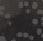

LAY-A-WAY • FREE DELIVERY • SE HABLA ESPAÑOL 407640N122822 NEW YORK AVE. FURNITURE 1946 NEW YORK AVE HUNTINGTON STATION NY 11746 631-923-2351 631-923-2352 Fr O Family to Y r Family, We Wish Y A Happy New Ye ! NOW OPEN TO THE PUBLIC Wholesale Seafood Since 1973 YOUR SEAFOOD HEADQUARTERS 440 FALMOUTH RD. • WEST BABYLON 631-422-0517 North Of Sunrise Highway From Southern State: Exit 37 South. 6/10 Mile On Belmont Ave. Left Onto Hubbards Path. Go 6/10 Mile. Left Onto Neptune. Go 3/10 Mile To Falmouth. From Sunrise Hwy: Exit 39 North Onto Hubbards Path. Go 2 Blocks. Right Onto Neptune. Go 3/10 Mile To Falmouth. HOURS: MON. - FRI. 9AM-5PM; SAT. 8AM-3PM • SUN 9AM-3PM www.captreeclam.com FRESH FROZEN FLOUNDER ....... $8.95 lb. BACCALA............ $11.95 lb. CALAMARI CLEANED MONTAUK........$10.00 lb. SCUNGILLI............ $ MP LARGE HIGH QUALITY - LOW PRICES SHRIMP HOLIDAY DELICACIES LOBSTER COOKED 31/40 ................. $8.95 lb. EZ PEEL 31/40.................. $5.95 lb. PEELED & DEVEINED 26/30.............. $7.95 lb. OPEN 7 DAYS TILL CHRISTMAS Southern State Exit 37 Exit 39 North Service Road Sunrise Hwy. SEAFOOD Neptune Ave. Route 109 Route 231 Belmont Ave. Hubbards Path 407740AN122822 BABY ROCK TAILS ........ $19.95 2 Oz. LIVE LOBSTER ...................... $ MP BIG ROCK $ MP AND MORE AND MORE SHELLFISH L.I. OYSTERS ..... $11.95 Doz. BAY SCALLOPS $11.95 lb. BAKED CLAMS .... $6.95 6 Pcs. MUSSELS ............ $3.50 lb. FRESH CLAMS $6 Doz. AND MORE IT'S COLD OUTSIDE, BUT IT'S ALWAYS WARM AT URBAN AIR LAKE GROVE! Scan, head to urbanairlakegrove.com or visit the park to purchase admission tickets! URBAN AIR LAKE GROVE 3147 MIDDLE COUNTRY RD, LAKE GROVE 631.861.4125 PLUS, WE'RE VOTED #1 FOR BIRTHDAY PARTIES! WEST BABYLON NORTH EDITION PUBLISHED BY LONG ISLAND MEDIA GROUP VOLUME 69 • NO. 17 Scan To View This Edition Online! This Edition Is Sponsored By: Want Advertising Info? Call 631.226.2636 x239! Find Us On Facebook & Instagram: Long Island Media Group DECEMBER 28, 2022 PRSRT STD ECRWSS U.S. POSTAGE PAID PERMIT NO. #187 *****************ECRWSS*** POSTAL CUSTOMER We Wish You A Peaceful & Happy New Year! for Tots program! Councilman Terence McSweeney recently joined with Councilman DuWayne Gregory, Town Clerk Gerry Compitello, Receiver of Taxes Jennifer Montiglio, and Town of Babylon staff members to get a batch of toys ready to be handed off to the U.S. Marine Corps, who provided the items to those in need. Your generous contributions helped brighten up the holiday season for so many children.































2 WEST BABYLON NORTHSOUTH BAY’S NEIGHBOR NEWSPAPERS WEDNESDAY DECEMBER 28, 2022 • WWW.LONGISLANDMEDIAGROUP.COM Police, Firemen, EMT, Educators, Medical Professionals, Military Local Hero Discount 10% Off For All Call For Details Or Stop In FLATS FIXED FREE Expires 1/18/23 PRE-PURCHASE INSPECTION We Will Thoroughly Check Out Your Used Car Purchase. $8999 Buying A Used Car? Don’t Buy A Lemon! COURTESY RIDES PICK-UP & DELIVERY SERVICE FOR YOUR CAR TO AND FROM HOME, WORK OR TRAIN STATION. Lube, Oil Change & Filter $3575 Expires 1/18/23 Some Car Filters & Oil May Be Higher REG. $39.99 + TAX INCLUDES: • Mileage Maintenance Schedule Check • 5W-30, 5W-20 Oil (Up To 5 Qts. Oil) • Filter • Check All Fluids & Tire Pressure Full Synthetic Oil Change $5875 Expires 1/18/23 + TAX INCLUDES: • Up To 5 Qts. Oil • Filter (Some Filters Higher) • Check All Fluids & Tire Pressure We F Ev ything! $29 OFF Screeching Brakes? We Can Help Don’t Wait Till It’s Too Late... FRONT OR REAR BRAKES Cannot Be Combined With Any Other Coupon Or Offer. 12 MONTH OR 12,000 MILE WARRANTY Expires 1/18/23 Check Engine Light On? ABS Light On? Scan For Codes Only FREE $20 OFF $10 OFF GET READY FOR WINTER ANY WORK OVER $100 OR MORE ANTIFREEZE SERVICE Expires 1/18/23 Excludes Oil Changes, NYS Inspections, Batteries, & Tires. Cannot Be Combined With Any Other Coupon Or Offer. Expries 1/18/23 1041 Little East Neck Rd. • West Babylon 631 539-0930 1 Block North Of CVS In Sunoco Station 407753N122822 LOOKING FOR SHADOW? LOOKING FOR JOHN? Same Great Location With A New Name!! SERVICE & TIRES
Written by Barry Klitsberg, Nassau County Medicare Counselor, FCA
For those of us who are enrolled in the Medicare program, there is good news on the horizon. Medicare has made significant changes to its premiums and deductibles, lowering the cost to the beneficiary.


While the cost of just about everything has gone up, the monthly Medicare Part B premium has been reduced for the first time this century, from $170.10 to $164.90, for a yearly saving of $62.40. What’s more, the Medicare Part B deductible has gone down from $233 per year to $226. These two reductions have broken a string of yearly increases.

Medicare Part B generally covers medically necessary services, that is, services or supplies that are needed to diagnose or treat your medical condition and that meet accepted standards of medical practice. Part B also covers a wide range of preventive services from shots to screenings to prevent illness (like the flu) or detect it at




an early stage, when treatment is most likely to work best.



In addition, due to the passage of the Inflation Reduction Act, Medicare will finally be able to negotiate prescription drug costs directly with pharmaceutical manufacturers. While this section of the law doesn’t go into effect until 2025, in the interim, beneficiaries who are insulin dependent can have their insulin costs capped at $35.00 per month. This can save hundreds of dollars a month. Also, the Inflation Reduction Act calls for out of pocket prescription expenses


to be capped at $2,000 annually.


In order to determine which type of plan works best for you, you should call the Nassau County Health Insurance Information Counseling and Assistance Program, HIICAP hotline. This is a free service that will guide you to the best plan for you. We have no affiliation with insurance companies, agents or brokers. Our number is 516-485-3754. While we are quite busy during Medicare Open Enrollment Season, we strive to return every call on our voice mail within two working days, and usually call sooner.
FCA can help. Answers to your Medicare questions are just a phone call away.











Barry Klitsberg is an Assistant Health Insurance Information Counseling and Assistance (HIICAP) Coordinator at FCA in Garden City and an Aging Services Program Specialist at US Department of Health and Human Services.


Holiday Model Train Exhibit At Old Town Hall
For the first time in two years, the Town of Babylon History Museum is proud to present the annual Holiday Model Train Exhibit at Old Town Hall, 47 W. Main Street in Babylon Village. Each December, the History Museum, and the Babylon
Town Historical Society feature an interactive model train display (240 sq. ft) that highlights historic points of interest from the Town of Babylon.
As we celebrate our 150th anniversary this year, we invite you to bring your kids to Old Town Hall


to see the model train display, which will be open Fridays, Saturdays and Sundays until January 1, 2023, from 12 noon to 3:00 p.m.


For more information, please call the Historian’s Office at (631) 587-3750.

3 WEST BABYLON NORTHSOUTH BAY’S NEIGHBOR NEWSPAPERS WEDNESDAY DECEMBER 28, 2022 • WWW.LONGISLANDMEDIAGROUP.COM INCOME TAX PREPARATIONS NEW YORK SOCIETY OF INDEPENDENTS ACCOUNTANT MEMBERS OF THE NATIONAL SOCIETY OF PUBLIC ACCOUNTANTS 22+ YEARS IN BUSINESS 247 Arnold Ave. West Babylon, NY 11704 Cell: (347) 451-7028 aldoincometax@gmail.com Aldo F. Cotrina Tax Preparer SERVICES OFFERED: • Individual Tax Declaration • Corporate or Business Income Tax Declaration • Quarterly Sales and Use Tax • NYS Insurance Fund Audit • Business License (Home Improvement, Restaurant License, Liquor License, Deli License) • Audit from the IRS and NYS • Application for the ITIN and EIN 407624N122822 407457N122822 1-800-698-5200 LEVITTOWN • SMITHTOWN • LONG BEACH TREAT YOURSELF! HEAR FOR THE HOLIDAYS! NEED A NEW HEARING INSTRUMENT? SPARE OR BACKUP? CHOOSE A HOLIDAY OPTION! OPTION 1: BUY ONE INSTRUMENT AT 20% OFF OPTION 2: BUY ONE INSTRUMENT GET SECOND 50% OFF BATTERIES BY THE CARTON BUY ONE GET ONE AT 50% OFF REPAIRS 10% OFF REPAIR LAB ON PREMISES HURRY! SALE EXTENDED THRU SAT, 1/14/23! BEAT THE PRICE INCREASE STARTING 1/16/23 • SORRY NO RAINCHECKS Medicare Lowers Premiums And Deductibles



4 WEST BABYLON NORTHSOUTH BAY’S NEIGHBOR NEWSPAPERS WEDNESDAY DECEMBER 28, 2022 • WWW.LONGISLANDMEDIAGROUP.COM GAS HEAT CHECK UP ANY NEW HEATING OR A/C SYSTEM $99 $1000 OFF Coupon must be presented at time of service. Cannot be combined with any other offers. Some restrictions apply. Expires 1/31/23. 407742N122822 Coupon must be presented at time of service. Cannot be combined with any other offers. Some restrictions apply. Expires 1/31/23. 631-464-0155











5 WEST BABYLON NORTHSOUTH BAY’S NEIGHBOR NEWSPAPERS WEDNESDAY DECEMBER 28, 2022 • WWW.LONGISLANDMEDIAGROUP.COM SCAN TO VISIT OUR WEBSITE Any Sale Item Less Than HALF POUND Will Be Charged Full Price DELI SPECIALS SEAFOOD GARLIC BREAD Fresh Daily ITALIAN BREAD FOR 3 $399 $349 SPECIALS CHEESE FRESH FRUITS & VEGETABLES GROCERY ROMANO & LOCATELLI CHEESE Grated Daily NOT RESPONSIBLE FOR TYPOGRAPHICAL ERRORS $1399 Why Go Anywhere Else... Best Prices In Town 407745N122822 SUNDAY ONLY ROLLS 6/$299 FRESH ATLANTIC SALMON OCTOPUS FRESH OYSTERS SEA SCALLOPS ALASKAN KING CRAB LEGS TILAPIA $299 LB. $1099 LB. $1099 $1799 $899 $1499 $2199 $1799 $249 LB. LB. LB. JUMBO SWEET MANGOS RED DELICIOUS APPLES HONEY CRISP APPLES ESCAROLE & CHICKORY GRANNY SMITH APPLES SMALL ORANGES SEEDLESS RED & GREEN GRAPES GREEN ZUCCHINI HALO CLEMENTINES GRAPE TOMATOES BABY CARROTS BUNCHED BROCCOLI KALE & COLLARD GREENS GOLDEN DELICIOUS APPLES SHRIMP 31-35 SHRIMP 13-15 SHRIMP 16-20 KING WILD SALMON JUMBO SHRIMP COCKTAIL P.F. FRESH FRESH FRESH P.F. 6/$799 $1399 $699 $499 $699 $1999 $899 LB. LB. LB. LB. LB. DZ. TUNA #1 SWORDFISH COD LITTLE NECK & CHERRY STONE FRESH SARDINES LB. BASA FILET LB. PINT $899 $1699 $999 $4299 STELLA FONTINELLA CHEESE $899 $1199 LB. IMPORTED FROM ITALY GRISSIN BON CLASSIC WHOLE WHEAT TOAST ARTIKAAS GOUDA IMPORTED VANTIA PRIMO SALE PLAIN OR w/PEPPER $359 $499 8 OZ. 6 OZ. AURICCHIO PROVOLONE LOCATELLI CHUNK OR GRATED $299 7 Oz. Ea. $1099 $1299 $1199 LB. LB. LB. IMPORTED PARMIGIANO REGGIANO LB. LB. LB. LB. LB. EA. $1699 $849 FILIPPO BERIO 100% OLIVE OIL $3299 $2699 $1099 $1099 $699 $1399 LB. LB. $1799 LB. VESUVIO SLICING MOZZARELLA OUR OWN ROAST BEEF LAND O' LAKES AMERICAN CHEESE CITTERIO HOT OR SWEET SOPPRESSATA LB. NEGRONI PROSCUITTO COPPA SWEET OR HOT $549 $1099 LB. LB. $499 LB. LB. OUR OWN OVEN ROASTED TURKEY PROSCIUTTO DIPARMA $899 LB. LB. WE ACCEPT EBT CARDS & DEBIT CARDS HELP WANTED SEAFOOD, PRODUCE, DELI & MEAT DEPT. EXP. PREFERRED INQUIRE WITHIN 631-587-2848 FAX # 631-587-3090 997 Little East Neck Road, West Babylon & CATERING SALE DATES 12/28/22 - 1/10/23 STORE HOURS: Mon-Sat 8am-6pm Sun 8am-5pm Due To Market Fluctuations, All Prices Subject To Change Without Notice. GIFT CERTIFICATES LB. LB. LB. BOTTICELLI OLIVE OIL FIRST COLD PRESSED 2 LTR OR PURE OLIVE OIL 3 LTR TUSCANY EXTRA VIRGIN OLIVE OIL IMPORTED FROM SICILY BELLA SICILIA EXTRA VIRGIN OLIVE OIL OLIVE OIL $179 $189 $299 2/$6 LB. $999 $2799 $1499 U-10 JUMBO SHRIMP STUFFED FLOUNDER WITH CRABMEAT, MUSHROOMS, & SPINACH LOBSTER TAILS 6.7 OZ. OR 9 OZ. SCUNGILLI $149 $199 $149 $169 $199 EACH HOMEMADE CRAB CAKE BAY SCALLOPS LB. $399LB. HOT & SWEET THICK SAUSAGE $399 LB. HOMEMADE CHICKEN BURGERS PORK TENDERLOIN CHICKEN OR PORK SAUSAGE $599 $399 $499 LB. LB. LB. $899 LB. MEATS $799 LB. $249 COUNTRY STYLE PORK RIBS LB. $599LB. CHOICE EYE ROUND ROAST BEEF ALL VARIETIES STUFFED CHICKEN BREAST $649LB. $1699 GROUND CHICKEN PRE TRIMMED FILET MIGNON $1899 LB. CHOICE RIB ROAST $1299 LB. 8 LBS OR MORE $249 1/2 GAL. FERRARA TORRONE LAMONICA SCUNGILLI BALOCCO PANETTONE IMPORTED FROM ITALY MUSSETTI ESPRESSO GRANORO PASTA ALL REGULAR CUTS OR $3.99 EACH HOOD MILK TROPICANA ORANGE JUICE PRODUCT OF ITALY CUOCO CAPONATA EGGPLANT APPETIZER YOGA PEAR NECTAR RONZONI LASAGNA $1299 2/$7 HOMEMADE EGGPLANT CAPONATA $599 $699 BELGIOIOSO SLICING PROVOLONE $399LB. $599LB. HOMEMADE PORK BRACCIOLE $679 $189 $149 8 OZ. LB. EA. 29 OZ. CAN Reg. $21.99 100 Grams 3 LITER 33.8 OZ. 3 LTR 59 OZ. NATURE VEAL $1399 LB. LB. LB. LB. $299 LB. LB. LB. LB. $699 $799 LB. LB. AMERICAN CHEESE BOLOGNA MUENSTER CHEESE SWEET SLICE HAM $799 $599 LB. DOMESTIC OR IMPORTED BACON $699 $599 $499 SKINLESS BEEF FRANKS EACH $599 4/$199 $649LB. BELL & EVANS THIN SLICED CHICKEN CUTLETS $699LB. CITTERIO PREMIUM HAM CITTERIO HARD SALAMI $599 LB. LB. LB. VISIT OUR HOMEMADE SECTION STUFFED SHELLS 12 COUNT$649 TORTELLINI FRESH HOMEMADE FRESH CAVATELLI VODKA SAUCE FRESH $1049 QT. CHEESE RAVIOLI $1499 $1799 36 CT. JUMBO REG. $999 QT MEAT SAUCE MARINARA SAUCE FRESH HOMEMADE $899 QT MANICOTTI 6 COUNT $649 EACH PROSCIUTTO BREAD HOMEMADE $399 EACH 36 CT. 1 LB BAG FULL BAKERY ON PREMISES SPECIAL OCCASION CAKES BY ORDER CHOCOLATE CREAM PIE .................................. $799 BANANA CREAM PIE $799 CANNOLI CAKE $1699 NY STYLE CHEESE CAKE $1599 BUTTER COOKIES $1399 CASSATA CAKE ............................................... $1699 PIGNOLI COOKIES $2499 RAINBOW COOKIES ....................................... $1599 STUFFED CRUMB CAKE W/FRENCH CREAM $999 ALMOND HORNS .................................... 2 FOR $598 ASSORTED MINI PASTRIES $1399 CHOCOLATE OR RASPBERRY CIGARS ........... $299 BROWNIES $699 CANNOLI LARGE ................................................ $299 CARTOCCI W/CANNOLI CREAM $349 LINZER TARTS $299 PKG. LB. EACH EACH EACH EACH EACH EACH EACH EACH EACH EACH EACH EACH EACH Joe’s Italian $18.99 Ft. Joe’s American $18.99 Ft. Fried Chicken Cutlet w/Cheese $18.99 Ft. “Ultimate” Fried Chicken Cutlet .................. $20.99 Ft. Grilled or Fried Chicken Cutlet .................... $19.99 Ft. w/Roasted Peppers & Mozzarella Grilled Vegetable ........................................... $19.99 Ft. e Godfather................................................ $22.99 Ft. Fried Eggplant, Fresh Mozzarella & Roasted Peppers $19.99 Ft. FREE 1 LB SALAD PER FOOT 3-4-5-6 Ft. We Also Have Shapes & Numbers. Each Foot Serves 3-4 People SUPER GOURMET HEROS CATERING PLACE YOUR CATERING & HOLIDAY ORDERS BY DECEMBER 19TH SAUSAGE MEAT FOR STUFFING LB. LB. $249 $399 $1999 CHOICE SHELL STEAK 6 PK. 1 Lb Box Each COMBO EVERROAST CHICKEN & AMERICAN CHEESE COMBO GENOA & PROVOLONE CUT UP CHICKEN WINGS $399 LB. BLACK LABEL CHICKEN CUTLETS STUFFED PORK CHOPS JUMBO CHICKEN TENDERS CHOICE TRIMMED SKIRT STEAK BONE-IN MARINATED ASSORTED STEAKS SIRLOIN PEPPER STEAK SIRLOIN BEEF STEW MEATLOAF MIX BEEF, VEAL, PORK $399 $399 $599 $599 $389 LB. LB. LB. LB. LB. 3LB. BAG $299 EA. $399 12 OZ. WHILE SUPPLIES LAST LB. CHICKEN DRUMSTICKS $169LB. LB. • RABBIT • QUAIL • CAPON • PRIME RIB ROAST • STUFFED VEAL • SMOKED HAM • TURKEY • PORK OR LAMB CROWN ROAST • SPIRAL HAMS FOR YOUR HOLIDAY TABLE +TAX +TAX +TAX $17999 $25999 $37999 PARTY PACKAGES • 3 Foot Italian - American Hero • 1/2 Tray Chicken Marsala • 1/2 Tray Penne alla Vodka • 1/2 Tray Eggplant Parmigiana • 2 Dozen Dinner Rolls • 3 Foot Italian - American Hero • 1/2 Tray Chicken Francese • 1/2 Tray Baked Ziti • 1/2 Tray BBQ Style Spare Ribs • 1/2 Tray Eggplant Parmigiana • Large Tossed Or Caesar Salad • 3 Dozen Dinner Rolls YOUR CHOICE OF 1 FULL TRAY OF PASTA: Penne alla Vodka Or Baked Ziti YOUR CHOICE OF 1 FULL TRAY OF CHICKEN: Chicken Marsala Or Chicken Francese YOUR CHOICE OF 1 FULL TRAY OF MEAT: Sausage & Peppers Or Beef & Broccoli YOUR CHOICE OF 1 FULL TRAY OF VEGETABLE: Eggplant Parm Or Red Potatoes & Onions • Large Tossed Salad • Large Caesar Salad • 4 Dozen Dinner Rolls PACKAGE #1 (20-25) PACKAGE #2 (30-35) PACKAGE #3 (40-45) +TAX • 5 Foot Italian - American Hero • 1 Full Tray Penne Alla Vodka • 1 Full Tray Sausage & Peppers • 1 Full Tray Chicken Parmesan • 1 Full Tray Red Potatoes & Onions • 16” Cheese Platter • Large Tossed Salad • Large Caesar Salad • 5 Dozen Dinner Rolls PACKAGE #4 (55-60) $51999 LB. PRIME TOP ROUND LONDON BROIL $599 $1099 7.62 Oz. Box
Helping You Help Others
By Noelle Lambert
The Charity of the Month for December is EAC Network
EAC Network is a non-profit organization that empowers, assists and cares for individuals in need. Their objective is to reach individuals within our community through innovative programs that improve quality of life.

Their programs are lead by an outstanding leadership team along with exceptional volunteers. Seniors make up a large portion of the population on Long Island and EAC Network proudly serves them. Their Meals on Wheels program in Nassau County and their InHome Respite Services program helps seniors face challenges with dignity and resourcefulness.
Last year, the EAC Network provided over 180,000 home delivered meals to frail, disabled and homebound local seniors who fervently wish to remain in their own homes. Their nutritious meals, friendly visits and safety checks help seniors cope with three of the biggest threats of aging – hunger, isolation and loss of independence.

“We received a call from one of our clients recently who told us that the conversations with their Meals on Wheels driver have helped him cope with his wife’s passing,” said Robert Stricoff, Chief Development Officer at EAC Network. “You cannot put a dollar amount on how this program improved this couple’s quality of life and kept them together in the home that they loved and had so many positive memories at.”
According to a Brown University study in 2015, high-risk seniors receiving Meals on Wheels showed greater improvements in both mental and physical health, fewer hospitalizations and were less likely to fall. When you consider that the cost of one year for a senior to receive meals is less than one day in a hospital, it is a bargain and

money truly well spent.
Mary Coyle, Senior Director for Senior Services, Nutrition Education & Food Services at EAC Network said, “Providing food and comfort to our most vulnerable seniors is not a cost to the county, it is an investment. Well cared for and fed seniors strengthens our communities and lowers the overall cost to taxpayers.”
Furthermore, the Meals on Wheels program provides more than just food; drivers deliver a smile, friendly visit, companionship and socialization, all of which is valuable contact for those who live alone. Additionally, dependent on funding, birthdays are celebrated with a cake and pet owners may also receive pet food. To inquire about receiving or volunteering with Meals on Wheels in Nassau County, please contact Mary Coyle at (516) 992-0081 ext 206 or Mary. Coyle@eac-network.org. If
6 WEST BABYLON NORTHSOUTH BAY’S NEIGHBOR NEWSPAPERS WEDNESDAY DECEMBER 28, 2022 • WWW.LONGISLANDMEDIAGROUP.COM
nonprofit
to be
EAC Meals
WE HAVE OPENINGS FOR SCHOOL BUS DRIVERS Don’t miss an opportunity for a great job where you can serve your community and make good money doing it. We provide the training you need to obtain your
drivers
RETIREES WELCOME! • EASY TO DRIVE VANS • FREE CDL TRAINING EDUCATIONAL BUS TRANSPORTATION 631.789.2300 NEW JANUARY STARTING SALARIES BIG BUS $27.18/Hr Non-Benefit Rate VAN $24.41/Hr Non-Benefit Rate SIGN ON BONUS $2,500 FOR CDL DRIVER BUS AND VAN $500 FOR NON CDL DRIVERS WILL TRAIN QUALIFIED APPLICANTS WE OFFER: Flexible Hours • 401k Plans With Matching Funds Health Insurance • Life Insurance • Emergency Family Leave • Safety & Attendance Bonus Twice A Year CALL TODAY POSITIONS AVAILABLE FOR NASSAU AND SUFFOLK EARN EXTRA MONEY WHILE HELPING THE COMMUNITY NOW HIRING! CALL TODAY! • Positions Available For Mechanics & Bus Attendants • Become A NYS Certified School Bus Driver AND... Equal Opportunity Employment 407626N122822
your
would like
featured in this column, please call Noelle Lambert at 631.226.2636 x225 for consideration. www.eac-network.org
on Wheels driver Gary Stricoff delivers a meal and a smile to a senior in Nassau County
commercial
license.
Direct Support Program Award To Royal Paws In Babylon Village

On Monday, December 12th, Councilmen DuWayne Gregory and Terence McSweeney “pawsented” a Direct Support Program award to Royal Paws in Babylon Village. Royal Paws provides dog boarding services and training while also having dog treats and collars available for sale. Coowners Cindy and Taylor
Chiacchere along with their other trainers Laura and Dana are looking to give back to the community by training therapy service dogs that will assist veterans, firefighters, or police officers. Councilman McSweeney said, “As a 19year member of the FDNY you will see a lot of bad days. Normally we cope with our feelings by talking
to each other, however knowing there is help through a place like Royal Paws is comforting. I look forward to seeing more from them in the future.”
J-Squid, Vincenzo, Ranger, and Bruce are all training to become service dogs and soon will hopefully find people that they can help!
DIRECT SUPPORT PROGRAM AWARD TO ROYAL PAWS - On Monday, December 12th, Councilmen DuWayne Gregory and Terence McSweeney “paw-sented” a Direct Support Program award to Royal Paws in Babylon Village. Co-owners Cindy and Taylor Chiacchere along with their other trainers Laura and Dana are looking to give back to the community by training therapy service dogs that will assist veterans, firefighters, or police officers.
West Babylon Public Library
211 Route 109 West Babylon (631) 669-5445 Fax: (631) 669-6539 www.wbpl.us Nancy Evans, Director ***
Registration dates are for WBPL cardholders. Non-residents may register 14 days prior to program. Please note: These programs are offered virtually through Zoom. Registrants must have an email address to attend programs.
YOGA Wednesdays: January 4-25 WBA402 6-7 pm IN PERSON Join Evelyn Regan for this monthly yoga series. Nonrefundable/transferable fee for
the 4-week January session: $8.
ZUMBA Fridays: January 6-27 WBA432 10:15-11:15 am IN PERSON
Join Cindy Merkler for this monthly Zumba series. Nonrefundable/ transferable fee for the 4-week January sessions: $8.
THE HAMBONES Saturday, January 7, 2-3:30 pm WBA718
VIRTUAL
Join us for the musical stylings of The Hambones.
MEDITERRANEAN COOKING Monday, January 9, 7-8 pm WBA606 - IN PERSON
Join Middle Eastern Chef Naela Saman and learn to make some delicious Mediterranean favorites.
PAINTED SOAP DISPENSER Tuesday, January 10, 7-8:30pm WBA103 IN PERSON
Join Betty Cole at the Library and design your own soap dispenser. Space is limited, program fee must be paid within 48 hours of registration to secure your spot. Nonrefundable materials fee: $5.
ENGLISH: BEGINNERS Tuesday, January 10 & 24, 6:15-7:15 pm WBA200 IN PERSON
Join us for this monthly class to help enhance your English language skills.
7 WEST BABYLON NORTHSOUTH BAY’S NEIGHBOR NEWSPAPERS WEDNESDAY DECEMBER 28, 2022 • WWW.LONGISLANDMEDIAGROUP.COM
Town Names Kime Ave In North Babylon

“Andrew Spadafora Memorial Way”


























A street that once brought so much joy during the month of December has now been ceremoniously renamed after the man who was responsible for the smiles, awe, and wonder as thousands drove past his home dubbed the “Christmas House” on Kime Ave in North Babylon.
Andrew Spadafora created a Christmas spectacular that included over a million lights, a 40-foot train, 100 sheep, and more all the while raising hundreds of thousands of dollars for a local children’s hospital.










Supervisor Schaffer, Dep. Sup. Martinez, Councilmen McSweeney, and Gregory were joined
by Suffolk County Leg. Tom Donnelly, Gordon Canary from Sen. Phil Boyle’s office, and Suffolk County Executive Steve Bellone for the dedication of Andrew Spadafora Memorial Way along with his wife Elinor, family, friends, neighbors, and members of the Parkdale Civic Association.
ANDREW SPADAFORA MEMORIAL WAY - A street that once brought so much joy during the month of December has now been ceremoniously renamed after the man who was responsible for the smiles, awe, and wonder as thousands drove past his home dubbed the “Christmas House” on Kime Ave in North Babylon.



8 year old Lhaso Apso and 5 year old Yorkie mix. Bonded pair. The best of friends.

a “pawsitive” attitude.













8 WEST BABYLON NORTHSOUTH BAY’S NEIGHBOR NEWSPAPERS WEDNESDAY DECEMBER 28, 2022 • WWW.LONGISLANDMEDIAGROUP.COM YEARLY EXAMS • Heartworm Test • Yearly Vaccinations • Fecal Test SENIOR DOGS • Weight Management • Hip Problems BOB CORONA, DVM (631) 376-1133 • 975 Little East Neck Rd. W. Babylon 1/2 Mile North Of Sunrise Hwy. Science Diet NEW HOURS! Mon.-Fri. 8am-6pm • Sat. 8am-1pm 407225N122822 Dr. Bob Corona STILL PRIVATELY OWNED & OPERATED BY DR. BOB CORONA OVER 27 YEARS! Low Cost Spays & Neuters Protect Your Pets With Frontline & Heartguard Happy New Year! NEW GROOMER CINDY IS HERE! CALL TODAY FOR AN APPOINTMENT NEW CLIENTS ALWAYS WELCOME ANIMAL HOSPITAL All Pets ALL ABOUT SPAY NEUTER • 4209 MERRICK ROAD, MASSAPEQUA • 516.799.CATS EMBER Sweet and playful female kitten with green eyes and loves to talk. TONI Black and white young female. Very sweet with personality. TINKERBELL Beautiful brown Tabby. She has 3 legs, but doesn’t know it. Loves attention LYRIC & SUSAN Young females. Seeking their forever homes Neighbor Pets’ Place Adopt a pet today! To inquire about having your shelter included in this column, email info@longislandmediagroup.com! LITTLE SHELTER • 33 WARNER ROAD, HUNTINGTON • 631.368.8770 BROOKHAVEN ANIMAL SHELTER • 300 HORSEBLOCK ROAD, BROOKHAVEN • 631.451.6950 BARNEY 5-7 year old male. Gentle soul. Looking for a family to love. DAHLIA 4-5 year old female. Happy
and sweet girl who loves to sit right beside you.
GIA 8 year old female. Full of life with lots of energy and happiness to share.
PEPPERMINT PATTY 1-2 years old male. Loves going out for walks, playtime and running.
PEPPERCORN
12 year old male. Terrier Mix. Active senior. Full of spunk and mischief. Sweet natured.
OLD MAN JENKINS 8 year old male. Labrador mix. The perfect companion to have by your side.
WOBBLES 2 year old male. Pit mix. Affectionate. Handsome boy with
HERMAN & LILY




















































































































































































































































































































































































































































































































































































9 WEST BABYLON NORTHSOUTH BAY’S NEIGHBOR NEWSPAPERS WEDNESDAY DECEMBER 28, 2022 • WWW.LONGISLANDMEDIAGROUP.COM ONLY $2395 Pick Up Or Free Delivery + Tax With Coupon Only. Must Mention Coupon When Ordering. Cannot be Combined. Expires 1/4/23 Plus 2 Liter Soda OVER STUFFED HOT HEROES Choose Any 2: Potato & Eggs Hero Meatball Parm Hero Sausage Parm Hero Chicken Parm Hero Sausage & Peppers Hero Eggplant Parm Hero e Original - Brick Oven of Lindenhurst FREE DELIVERY $15 MINIMUM 51A West Hoffman Ave. (Corner South 2nd Street) (631) 225-4444 TRY OUR 2ND SPICESTREET PIZZA! 407692N122822 ONLY$1795 + Tax With Coupon Only. Must Mention Coupon When Ordering. Cannot be Combined. Expires 1/4/23 WOW SUPER SPECIAL 18” XTRA LARGE PIE Pick Up Only COMPLETE FAMILY TABLE Choose Any 2 Dinners Served With 12 Garlic Knots, 2 House Salads, 2 Desserts (Chocolate Pudding Or Rice Pudding) Choices: Baked Ziti Penne Alla Vodka Baked Lasagna Baked Ravioli Penne Carbonara Spaghetti & Meatballs ONLY $2995 Pick Up Or Free Delivery + Tax With Coupon Only. Must Mention Coupon When Ordering. Cannot be Combined. Expires 1/4/23 Family That Eats Together Stays Together ONLY $3195 Pick Up Or Free Delivery + Tax Spasso’s Famous MEAT LOVER’S PIZZA 18” EXTRA LARGE PIZZA 18” EXTRA LARGE PIZZA • Meatballs, Pepperoni & Sausage Smothered In Extra Cheese • 6 Garlic Knots • 6 Garlic Knots • Plus FREE 2 Liter Soda • FREE 2 Soda With Coupon Only. Must Mention Coupon When Ordering. Cannot be Combined. Expires 1/4/23 With Coupon Only. Must Mention Coupon When Ordering. Cannot be Combined. Expires 1/4/23 • 18” Extra Large Pizza • Choice Of Meatball, Eggplant Or Sausage Parmigiana Hero • Baked Ziti or Lasagna • House Salad • 12 Garlic Knots • 2 Liter Soda ONLY $4195 Pick Up Or Free Delivery PARTY PACK + Tax With Coupon Only. Must Mention Coupon When Ordering. Cannot be Combined. Expires 1/4/23 • 18” Xtra Large Pizza • 12 Buffalo Wings • 12 Garlic Knots ONLY $3595 Pick Up Or Free Delivery + Tax Joseph & Malina & The Whole Spasso’s Family Would Like To Wish Everyone A Happy & Safe New Year! OPEN NEW YEAR’S EVE 12PM-8PM NEW YEAR’S DAY 1PM-9PM AUTHORIZED DEALER As a New York State essential business, we have made adjustments in our business practices in accordance with the CDC recommendations to help STOP the spread of the COVID-19 virus, during our installations. Generac Automatic Standby Generator (631) 544-0400 128 Pulaski Road, Kings Park, N.Y. 11754 www.GetGenReady.com • office@GetGenReady.com • Licensed and Insured NASSAU LICENSE #H0107000000 SUFFOLK LICENSE# 2740-ME *WITH THIS AD ONLY. RESTRICTIONS MAY APPLY 197 9 202 2 43rd ANNIVERSARY K I NGS PAR K , NEW Y O R K • GEN R E ADY • 0% Financing Available* Never be without power again! The best time to buy your stand by generator is when you don’t need it. • Flex Financing • Permits and Filing • Certified Factory Trained Installers • Full Product Support • Warranties and Service • Installation and Repair August 4, 2020 Tropical Storm Isaias: 331,000 PSEG Long Island customers were without power as damaging winds pounded the area. SOURCE: psegliny.com Our new Sales Center is open. Please call for an appointment. FREE EXTENDED WARRANTY!* 407669N122822 AN T IQU E & ESTATE BUY ERS We buy anything old. One piece or house full WILL TRAVEL. HOUSE CALLS. WILL TRAVEL ENTIRE TRI-STATE! TOP $ PAID FOR JUDAICA COLLECTIBLES HOUSE CALLS Same day Service available Will Travel. We make house Calls. 1029 WesT JeriCho Turnpike, smiThToWn, l.i. Will Travel. We make house Calls. 37W 47Th sT, nYC Same day Service available House Calls Serving brooklyn and the entire t ri-State area We Pay $ Cash $ for all Gold, Gold & sTerlinG silver CosTume JeWelrY, all Coins, paper moneY & sTamp ColleCTions all Gold...Broken or noT pre- 1960 FurniTure, CloCks & WaTChes (WorkinG or noT) TiFFanY, BaCCaraT, lalique ANTIQUES AN d E STATE B UyE rS Free e stimate Silver Gold Coins • Top $ Paid, Herrend, Meissen, KPM Etc., Antique Chinese & Japanese Art, Jade Coral Pottery Etc, Bronze Sculpture, All Musical Instruments, LP Records, Vintage Toys...Pre 1970, Persian & Oriental Rugs, Oil Paintings & Comic Books, Hummels & LLadro......The l ist is e ndless yE Military Collections Wanted Swords, Knives, Helmets, etc. www.antiqueandestatebuyers.com aSk for chriS toPher Top $ Paid for a ntique Sterling! ks Top $ Paid for Diamond & Estate Jewlery 404125N122822 173 N. WELLWOOD AVE., LINDENHURST 11757 k 516-974-6528

































10 WEST BABYLON NORTHSOUTH BAY’S NEIGHBOR NEWSPAPERS WEDNESDAY DECEMBER 28, 2022 • WWW.LONGISLANDMEDIAGROUP.COM FOR • Postal Services • Notary Services • UPS Services • Returns • Fax Services • Packing Services • Shredding Services 1488 Deer Park Ave., North Babylon, NY 11703 • 631.242.6245 Store Hours: Sunday 10AM-3PM • Monday - Friday 8AM-6:30PM • Saturday 8AM-3PM RETURN CENTER RETURNS ACCEPTED FROM ALL MAIL CARRIERS 50% OFF OPEN 7 DAYS A WEEK NEW 3 MONTH MAILBOX RENTAL With Coupon. Cannot Be Combined With Any Other Offer or Sale Item. Offer Expires 12/24/22. 407749N122822 407438N122822 Not Responsible For Typographical Errors. Hours: Mon. - Thurs. 11am-10pm Fri., Sat. 11am-11pm Sun. 12Noon-10pm 133 N. WELLWOOD AVE. LINDENHURST Just North Of Hoffman Ave. (Railroad Ave.) On The West Side www.MrGsPizzeriaofLindenhurst.com Follow Us On & WE DELIVER $15 Min. Lindenhurst FREE LOCAL DELIVERY (631)226-6336 COUPON COUPON COUPON COUPON COUPON COUPON COUPON COUPON COUPON COUPON COUPON COUPON COUPON COUPON COUPON COUPON FAMILY FEAST 2 LARGE PIES WITH 1 FREE TOPPING ON 1 PIE ONLY + FREE 2 LITER SODA BAKED ZITI, BAKED RAVIOLI, SPAGHETTI & MEATBALLS OR WHITE CLAM SAUCE, PENNE ALLA VODKA, SAUSAGE & PEPPERS SERVED WITH GARLIC KNOTS, TOSSED SALAD, AND A SLICE OF CHEESECAKE Reg. $48.95 +TAX Mention Ad With Order • Expires 1/4/23 Mention Ad With Order • Expires 1/4/23 Mention Ad With Order • Expires 1/4/23 $3499 $3199 $1595 + Tax + Tax + Tax + Tax P I Z Z A 1 LARGE CHEESE PIZZA 1 Dozen Garlic Knots 1 Dozen Mozzarella Sticks 1 (2) Liter Pepsi $3499 SICILIAN PIE 12 Slices Reg. $24.75 +TAX $2299 + Tax EXTRA LONG HEROS Reg. $38.95 +TAX Your Choice $2899 3 PARMIGIANA HEROS + Tax • Chicken • Meatball • Eggplant • Sausage (Excludes Veal Or Shrimp) EVERYDAY FAMILY SPECIAL • 1 Large Cheese Pie • 1 Baked Ziti With Ricotta • 1 Meatball Parmigiana Hero • 1 - 2 Liter Pepsi • 1 Dozen Garlic Knots Reg. $54.75 +TAX No Substitutions • Pick-Up Or Delivery Mention Ad With Order • Expires 1/4/23 Free Delivery With Mention Of Ad. Expires 1/4/23 Free Delivery With Mention Of Ad. Expires 1/4/23 Free Delivery With Mention Of Ad. Expires 1/4/23 Free Delivery With Mention Of Ad. Expires 1/4/23 $4099 + Tax LARGE PIE MEAT LOVER’S PIZZA 6 FREE GARLIC KNOTS Sausage, Meatballs, Pepperoni & Bacon With (1) 2 Liter Pepsi Reg. $23.50 + TAX TAKE-OUT$1749 + Tax Reg. $45.50 +TAX CHOOSE ANY DINNER CURBSIDE PICKUP AVAILABLE Scan For Our Menu & Order Reg. $41.50 +TAX Holiday Catering 10% OFF Place Your Order Now Happy New Year From All Of Us At Mr.G’s Pizza

11 WEST BABYLON NORTH SOUTH BAY’S NEIGHBOR NEWSPAPERS WEDNESDAY DECEMBER 28, 2022 • WWW.LONGISLANDMEDIAGROUP.COM STORE HOURS: Mon.-Fri. 8am-7pm, Sat. 8am-6pm • Sun. 9am-4pm Not Affiliated with the North Bellmore location WANTAGH 3457 Merrick Rd. • 516-221-1100 N. BABYLON 38 Deer Shore Square • 631-242-5500 Call and place your order today! | Store Hours: Mon.-Fri. 8am-7pm • Sat. 8am-6pm • Sun. 9am-4pm • New Year’s Eve Hours, 12/31 8am-6pm. Closed New Year’s Day Wantagh, 3457 Merrick Rd., (516) 221-1100 | N. Babylon, 38 Deer Shore Square, (631) 242-5500 Available at Salpino of Wantagh and North Babylon locations only. Not affiliated with Salpino of North Bellmore. USDA Prime Omaha USDA Prime Meat Imported From Italy Divella Dolcenella Hazelnut Chocolate Spread $3.49 ea. 400g 3 Foot Hero (Sliced) Italian, American or Chicken Cutlet with Fresh Mozzarella & Roasted Peppers 3 Pounds of Salad Homemade Macaroni Salad, Homemade Potato Salad or Homemade Coleslaw Penne Alla Vodka & Mini Rice Balls Half Trays First Course (Choose one) Pasta: • Penne • Baked Ziti • Spaghetti • Rigatoni • Stuffed Shells (16 pc) • Manicotti (8 pc) • Jumbo Cheese Ravioli (16 pc) Second Course (Choose one) Entree: • Chicken Marsala • Chicken Francese • Eggplant Parmigiana • Chicken Parmigiana • Sausage & Peppers • Chicken with Sundried Tomatoes & Broccoli • Eggplant Rollatine • Meatballs • Grilled Skirt Steak - $20 extra • Vodka Sauce • Tomato & Basil • Marinara • Garlic & Oil • Bolognese Choice of Sauce: Call and place your order today! Wantagh (516) 221-1100 | Babylon (631) 242-5500 • Available at Salpino of Wantagh and North Babylon locations only. Not affiliated with Salpino of North Bellmore. Buon Appetito! $ 3999 plus tax Serves minimum of 4 people Family Dinner Special Available to order for New Year’s Eve by 12/29 $15999 plus tax Available to order for New Year’s Eve by 12/29 407754N122822 Not responsible for typographical errors. 407602AN122822 10% OFF (631) 487-0939 • (516) 417-8403 Lenny Mannino Master Electrician Licensed & Insured FREE ESTIMATES 0% INTEREST
BLACK IRISH IRISH CREAM



BAILEY'S IRISH CREAM
$29.99
GREY GOOSE VODKA....................... $28.99




HERRADURA BLANCO $32.99

COURVIOUSIER $29.99








BROCKMANS GIN





CASAMIGOS BLANCO
CLASSIC MALT 3 BTL 200 ML


$26.99
$48.99
$62.99



JACK DANIELS APPLE $27.99
JACK DANIELS FIRE
JACK
JOHNNIE WALKER BLACK

TEQUILA ROSE
$36.99
$20.99
MARTELL VSOP $44.99




FIREBALL PONG SET $17.99
JAMESON BLACK BARREL.............. $42.99















DOUBLE CROSS VODKA

BULLEIT BOURBON



$27.99

$25.99
$32.99
AMARETTO DISORRONA VELVET $26.99























TEXANO REPOSADO BOOT
$59.99







12 (631) 487-0939 FREE ESTIMATES 0% INTEREST $ 5000 Sign On Bonus ask for details NOW HIRING FULL TIME/PART TIME - CALL TODAY $ 20- $ 55 plus per hour COMPETITIVE PAY • PAID VACATIONS PAID HOLIDAYS • ROTH IRA PENSIONS 400141AN042022 WEST BABYLON NORTH SOUTH BAY’S NEIGHBOR NEWSPAPERS WEDNESDAY DECEMBER 28, 2022 • WWW.LONGISLANDMEDIAGROUP.COM Wishing Everyone A Very Happy New Year! This advertisement is a coupon requiring customers to bring advertised item to get advertised price. All items may not be available in both stores. Each store independently owned and operated. Not responsible for typographical errors. Under State law, any package store is entitled to buy any item of liquor or wine shown in this advertisement at the same price paid by the stores listed in this ad.The listed stores are independently owned and operated. They are not a chain and are not a cooperative buying group. 407668GN122822 631-226-3965 111 W. HOFFMAN AVE. • LINDENHURST CORNER OF SOUTH FOURTH STREET HOURS: MON. - THURS. 9 AM - 8 PM FRI. - SAT. 9 AM - 9 PM • SUN. NOON - 6 PM EXOTIC WAREHOUSE WINES & LIQUORS LLC With Coupon. Expires 1/4/23 WB LIQUOR GIFT SETS 750 ML With Coupon. Expires 1/4/23 WB WESTERN SON BUCKETS $1599 With Coupon. Expires 1/4/23 WB MOET & CHANDON DOM PERIGNON $23999 With Coupon. Expires 1/4/23 WB UGLY SWEATER RED ROSE WHITE $699 750 ML
.............
$24.99
...................
.............................
......................
..........
..........................
.................
DANIELS OLD NO. 7
$27.99
...............
..................................
..................
..........................
.............
WE ACCEPT ALL LOCAL COMPETITORS' COUPONS UNLESS WE DEEM A TYPOGRAPHICAL ERROR OR MISPRINT Coupons Good Only While Supplies Last We Bring You The LARGEST Selection Of Wines & Liquors At Our EVERYDAY LOW PRICES!! With Coupon. Expires 1/4/23 WB LANETA REPOSADO 750 ML With Coupon. Expires 1/4/23 WB FIREBALL BURNDOWN TO NYE $17 99 750ML With Coupon. Expires 1/4/23 WB SWEDISH HILLS SLEIGH BELLS 750ML $799 $10799 JIM BEAM 1.75 L $26.99 BASIL HAYDEN LITER ......... $49.99 BUFFALO TRACE 750 ML .... $28.99 With Coupon. Expires 1/4/23 WB BOURBON With Coupon. Expires 1/4/23 WB With Coupon. Expires 1/4/23 WB WHITE WINES JUG WINES DR LOOSEN RIESLING 750 ML $9.99 FOLONARI PINOT GRIGIO 1.5 L $10.99 CONUNDRUM 750 ML $17.99 CHANGE SAUVIGNON BLANC 1.5 L $13.99 CAKEBREAD CHARDONNAY 750 ML $38.99 LOUIS JADOT MACON VILLAGES 750 ML $12.99 LIVINGSTON CABERNET SAUVIGNON $16.99 VILLA ARMANDO RUSTICO $19.99 OPICI BARBERONE .......................................... $15.99 YAGO SANGRIA ................................................ $14.99 TAYLOR LAKE COUNTRY WHITE $13.99 PASO A PAS TEMPRANILLO $9.99 MARKHAM CABERNET SAUVIGNON ...... $32.99 ELOUAN PINOT NOIR $12.99 UNSHACKLED RED $19.99 With Coupon. Expires 1/4/23 WB RED WINES 750 ML JACK DANIELS ........... $46.99 DEWARS WHITE LABEL ..... $32.99 BALLANTINES ............ $28.99 With Coupon. Expires 1/4/23 WB SCOTCH/WHISKEY LIFEVINE CABERNET SAUVIGNON ........ $12.99 BEE ORGANIC PINOT NOIR $9.99 FREY VINEYARDS SAUVIGNON BLANC $12.99 BELLISSIMA PROSECCO $15.99 SAVION PINOT GRIGIO $9.99 With Coupon. Expires 1/4/23 WB ORGANIC WINES 750 ML ABSOLUT $26.99 KETEL ONE ..................... $36.99 LVOV................................. $18.99 With Coupon. Expires 1/4/23 WB VODKA 1.75 L






















































































13 (631) 487-0939 FREE ESTIMATES 0% INTEREST $ 5000 Sign On Bonus ask for details NOW HIRING FULL TIME/PART TIME - CALL TODAY $ 20- $ 55 plus per hour COMPETITIVE PAY • PAID VACATIONS PAID HOLIDAYS • ROTH IRA PENSIONS 400141AN042022 WEST BABYLON NORTH SOUTH BAY’S NEIGHBOR NEWSPAPERS WEDNESDAY DECEMBER 28, 2022 • WWW.LONGISLANDMEDIAGROUP.COM WINES & LIQUORS LLC AMITY-BABYLON WAREHOUSE Wine & Liquor 631-841-5531 860 MERRICK RD. / MONTAUK HWY. • COPIAGUE IN MERRINECK II SHOPPING CENTER FOOT OF GREAT NECK ROAD HOURS: MON. - THURS. 9 AM - 8 PM FRI. - SAT. 9 AM - 10 PM • SUN. NOON - 6 PM WE ACCEPT ALL LOCAL COMPETITORS' COUPONS UNLESS WE DEEM A TYPOGRAPHICAL ERROR OR MISPRINT Coupons Good Only While Supplies Last This advertisement is a coupon requiring customers to bring advertised item to get advertised price. All items may not be available in both stores. Each store independently owned and operated. Not responsible for typographical errors. Under State law, any package store is entitled to buy any item of liquor or wine shown in this advertisement at the same price paid by the stores listed in this ad.The listed stores are independently owned and operated. They are not a chain and are not a cooperative buying group. 407668HN122822 With Coupon. Expires 1/4/23 WB MOET & CHANDON LADY GAGA DOM PERIGNON $259 99 With Coupon. Expires 1/4/23 WB BLACK IRISH WHITE CHOCOLATE $2399 750 ML With Coupon. Expires 1/4/23 WB BROTHERHOOD HOLIDAY SPICE $1199 1.5 L With Coupon. PENNSYLVANIA DUTCH EGG NOG 750 ML With Coupon. Expires 1/4/23 WB FIREBALL BUCKETS $16 99 With Coupon. Expires 1/4/23 WB JACKSON MORGAN BROWN SUGAR & CINNAMON LIQUEUR 750 ML $1999 $899 With Coupon. Expires 1/4/23 WB 99 BRANDS • FIREBALL JACK DANIELS • JIM BEAM TRIPLE PLAY BASEBALLS WESTERN SON • RUM CHATA JACK DANIELS FIRE MINI GIFTS LAMARCA PROSECCO ..... $14.99 KORBEL ALL TYPES ......... $12.99 DOMAINE CHANDON ROSE..... $15.99 With Coupon. Expires 1/4/23 WB SPARKLING 750 ML LA VIELLE FERME 1.5 L $12.99 DIVING INTO HAMPTON WATER 750 ML $16.99 GOOD F*CKING WINE 750 ML $12.99 SHE’S ALWAYS ROSE $11.99 With Coupon. Expires 1/4/23 WB ROSE 750 ML ASBACH URALT LITER $29.99 DEVILLE 1.75 L .................... $20.99 D'USSE VSOP 750 ML $44.99 With Coupon. Expires 1/4/23 WB BRANDY With Coupon. Expires 1/4/23 WB ORGANIC LIQUORS IRISH MIST LITER ................ $29.99 BAILEYS 750 ML .................. $29.99 GODIVA WHITE 750 ML ............. $23.99 GRAND MARNIER LITER .... $37.99 With Coupon. Expires 1/4/23 WB CORDIALS/CREAMS TEREMANA REPOSADO 750 ML .............. $36.99 ESPOLAN BLANCO LTR $29.99 CALIROSA ANEJO (ADAM LEVINE) 750 ML ............. $62.99 With Coupon. Expires 1/4/23 WB TEQUILA 750 ML OCEAN VODKA $24.99 CROP CUCUMBER VODKA $19.99 CASA NOBLE SILVER TEQUILA..................... $42.99 ENGINE GIN $34.99 BOMBAY BRAMBLE LITER $32.99 FLEISCHMANS 1.75 L ....... $14.99 GLENDALOUGH ROSE 750 ML $28.99 HENDRICKS LITER .......... $42.99 With Coupon. Expires 1/4/23 WB GIN BACARDI SILVER/GOLD $19.99 CAPTAIN MORGAN ..... $32.99 MALIBU........................ $29.99 With Coupon. Expires 1/4/23 WB RUM 1.75 L With Coupon. Expires 1/4/23 WB WINE GIFT SETS BOLLA 2 BTL ............................................................................... $17.99 BOLLA 4 BTL .............................................................................. $33.99 BAR DOG 2 BTL $22.99 19 CRIMES 2 BTL ........................................................................ $23.99 MEZZACORONA 2 BTL .............................................................. $22.99 MENAGE A TROIS 3 BTL ............................................................ $29.99 GRANNY’S GINGERBREAD CREAM $1199 With Coupon. Expires 1/4/23 WB 750ML EUROPEAN HOLIDAY OR CHRISTMAS SPARKLING MOSCATO $1099 With Coupon. Expires 1/4/23 WB 750ML RUMCHATA PEPPERMINT BARK $2199 With Coupon. Expires 1/4/23 WB 750ML SPARKLING WINES SPARKLING ROSE PROSECCO 750 ML 750 ML 750 ML VEUVE CLICQUOT YELLOW LABEL............................. $58.99 MOET & CHANDON IMPERIAL ....................... $48.99 GLORIA FERRER BLANC DE BLANC ......... $17.99 MARTINI & ROSSI ASTI . $12.99 KORBEL ALL TYPES ..... $13.99 VILLA JOLANDA CHRISTMAS .................... $11.99 BARTENURA .................. $12.99 BREAD & BUTTER......... $12.99 JOSH $12.99 FREIXENET $13.99 LAMARCA....................... $14.99 KIM CRAWFORD ............ $15.99 VEUVE CLICQUOT ......... $62.99 MOET & CHANDON ....... $69.99 SWING $11.99 BELLISSIMA $18.99 CUPCAKE ....................... $10.99 DEVANT .......................... $36.99 With Coupon. Expires 1/4/23 WB With Coupon. Expires 1/4/23 WB With Coupon. Expires 1/4/23 WB














































































































































































14 WEST BABYLON NORTH SOUTH BAY’S NEIGHBOR NEWSPAPERS WEDNESDAY DECEMBER 28, 2022 • WWW.LONGISLANDMEDIAGROUP.COM PLUMBING & HEATING SPECIALIST IF YOU HAVE BROKEN OR LEAKING WATER PIPES • DRAINS • HEATING • CAST IRON PVC • TOILETS • COPPER • BOILERS • WATER HEATERS 631-810-DUCK (3825) FREE TOILET INSTALLATION WITH PURCHASE OF ANY OF THE FOLLOWING: • 1 DAY SUPER BATH REMODEL: NEW TUB, NEW TILE, NEW SHOWER BODY ALL IN 1 DAY! AMAZING! • MAIN DRAIN / WASTE REPIPE • NEW BOILER INSTALLATION WE OFFER FINANCING LOW MONTHLY PAYMENTS OR NO INTEREST FOR 18 MONTHS 2 YEAR WARRANTY ON ALL REPAIRS & INSTALLATIONS $50 OFF ANY DRAIN 25 OFF ONE CALL DOES IT ALL! WE HAVE GREAT PRICING! PLUMBING • DRAIN • WASTE • SEWAGE WWW.RUBBERDUCKPLUMBINGINC.COM WE GIVE 5 STAR SERVICE NO ADDED FEE FOR NIGHTS OR WEEKENDS 407595BN122822 Garage Door Sale! 1607 Lakeland Ave., 631-218-8888 COMMERCIAL EXPERT Nassau Lic. #Hi601220000 LOW HEAD ROOM TRACK + $45.00 RE-HOOK MOTOR + $35.00 BRENTWOOD 2” Steel Uninsulated Garage Door Model 2250 - Glass Additional 2” Steel Insulated Polybacker Garage Door Model 4251 - Glass Additional Carriage CALL, EMAIL, SHOWROOM FOR NOTICE TO OUR CUSTOMERS Beware of Internet Imposters. We Are Not Affiliated With Any 800 Numbers or Other Please call us for high quality service and installations, by our in-house technicians. We offer quality products and expert installations. Garage Door Sale! 1607 Lakeland Ave., 631-218-8888 COMMERCIAL EXPERT Nassau Lic. #Hi601220000 LOW HEAD ROOM TRACK + $45.00 RE-HOOK MOTOR + $35.00 BRENTWOOD 2” Steel Uninsulated Garage Door Model 2250 - Glass Additional 2” Steel Insulated Polybacker Garage Door Model 4251 - Glass Additional Carriage CALL, EMAIL, SHOWROOM FOR A NOTICE TO OUR CUSTOMERS Beware of Internet Imposters. We Are Not Affiliated With Any 800 Numbers or Other Please call us for high quality service and installations, by our in-house technicians. We offer quality products and expert installations. Garage Door Sale! 1607 Lakeland Ave., 631-218-8888 COMMERCIAL DOORS EXPERT SERVICE LOW HEAD ROOM TRACK + $45.00 RE-HOOK MOTOR + $35.00 BRENTWOOD DOOR CO., 2” Steel Uninsulated Garage Door Model 2250 - Glass Additional 2” Steel Insulated Polybacker Garage Door Model 4251 - Glass Additional Carriage Garage CALL, EMAIL, OR SHOWROOM FOR A FREE NOTICE TO OUR CUSTOMERS Beware of Internet Imposters. We Are Not Affiliated With Any 800 Numbers or Other Please call us for high quality service and installations, by our in-house technicians. We offer quality products and expert installations. Garage Door Sale! COMMERCIAL DOORS SALES LOW HEAD ROOM TRACK + $45.00 RE-HOOK MOTOR + $35.00 $49500 INSTALLED Genie Garage Door Opener Model 2128 Chain Drive with 1 Remote, Fully Installed 2” Steel Uninsulated Garage Door Model 2250 - Glass Additional 2” Steel Insulated Polybacker Garage Door 8’x7’ Double Wall Steel Insulated-R10 Garage Door • SALES • SERVICE • SELECTION NOTICE TO OUR CUSTOMERS Beware of Internet Imposters. We Are Not Affiliated With Any 800 Numbers or Other Locations. Please call us for high quality service and installations, by our in-house technicians. We offer quality products and expert installations. Starting at $97500 Garage Door Sale! Suffolk Lic#14877H Nassau Lic. INSTALLED 2” Steel Uninsulated Garage Door Model 2250 - Glass Additional • SERVICE • SELECTION Beware of Please $97500 407619N122822 Low Head Room Re-Hook Motor +$35 COMMERCIAL DOOR SALES • EXPERT SERVICE & INSTALLATIONS Garage Door Sale! 1607 Lakeland Ave., Bohemia COMMERCIAL DOORS SALES EXPERT SERVICE Suffolk Lic#14877H Nassau Lic. #Hi601220000 LOW HEAD ROOM TRACK + $45.00 RE-HOOK MOTOR + $35.00 BRENTWOOD Mon.-Fri. 8-4:30 • Sat. 9-2 brentwoodgaragedoor.com $49500 INSTALLED Genie Garage Door Opener Model 2128 Chain Drive with 1 Remote, Fully Installed 2” Steel Uninsulated Garage Door Model 2250 - Glass Additional 2” Steel Insulated Polybacker Garage Door Model 4251 - Glass Additional 8’x7’ Double Wall Steel Insulated-R10 Garage Door CHI Model 2283 - Glass Additional Insulated Steel Carriage Garage Door Glass Included • Model 5251 • SALES • SERVICE • SELECTION CALL, EMAIL, OR VISIT OUR SHOWROOM FOR A FREE QUOTE TODAY! NOTICE TO OUR CUSTOMERS Beware of Internet Imposters. We Are Not Affiliated With Any 800 Numbers or Other Locations. Please call us for high quality service and installations, by our in-house technicians. We offer quality products and expert installations. Starting at NS-2171748101 $97500 159500 Garage Door Sale! 1607 Lakeland Ave., Bohemia 631-218-8888 COMMERCIAL DOORS SALES EXPERT SERVICE Suffolk Lic#14877H Nassau Lic. #Hi601220000 LOW HEAD ROOM TRACK + $45.00 RE-HOOK MOTOR + $35.00 BRENTWOOD DOOR CO., INC. Mon.-Fri. 8-4:30 • Sat. 9-2 brentwoodgaragedoor.com $49500 INSTALLED Genie Garage Door Opener Model 2128 Chain Drive with 1 Remote, Fully Installed 2” Steel Uninsulated Garage Door Model 2250 Glass Additional 2” Steel Insulated Polybacker Garage Door Model 4251 Glass Additional 8’x7’ Double Wall Steel Insulated-R10 Garage Door CHI Model 2283 - Glass Additional Insulated Steel Carriage Garage Door Glass Included • Model 5251 • SALES • SERVICE • SELECTION CALL, EMAIL, OR VISIT OUR SHOWROOM FOR A FREE QUOTE TODAY! NOTICE TO OUR CUSTOMERS Beware of Internet Imposters. We Are Not Affiliated With Any 800 Numbers or Other Locations. Please call us for high quality service and installations, by our in-house technicians. We offer quality products and expert installations. Starting at NS-2171748101 $97500 $105000 $129500 $159500 The ORIGINAL Brentwood Garage Door! In business for over 70 years, don’t be fooled by imitators! Wishing Everyone A Happy & Healthy Holiday! FEB 9th - April 2 nd Nov 10th - Jan 1st Broadway Comes to Babylon! argyletheatre.com | 631.230.3500 | 34 w. main street, babylon ny 11702 argyletheatre.com | 631.230.3500 | 34 w. main street, babylon ny 11702 $10 Off* WITH cOde: BAY *Not to be combined. Discount valid off individual, premium mainstage tickets only. 407226N122822 407602BN122822 10% OFF (631) 487-0939 • (516) 417-8403 Lenny Mannino Master Electrician Licensed & Insured FREE ESTIMATES 0% INTEREST NOW HIRING • FULL TIME/PART TIME
































15 WEST BABYLON NORTHSOUTH BAY’S NEIGHBOR NEWSPAPERS WEDNESDAY DECEMBER 28, 2022 • WWW.LONGISLANDMEDIAGROUP.COM CASH & CARRYNO LIMITCASH & CARRYNO LIMITCASH & CARRYNO LIMITCASH & CARRYNO LIMITCASH & CARRYNO LIMITCASH & CARRYNO LIMITCASH & CARRYNO LIMITCASH & CARRYNO LIMITCASH & CARRY CASH & CARRY - NO LIMIT - NOT RESPONSIBLE FOR TYPOGRAPHICAL ERRORS - NOT RESPONSIBLE FOR TYPOGRAPHICAL ERRORS - CASH & CARRY - NO LIMIT CASH & CARRYNO LIMITCASH & CARRYNO LIMITCASH & CARRYNO LIMITCASH & CARRYNO LIMITCASH & CARRYNO LIMITCASH & CARRYNO LIMITCASH & CARRYNO LIMITCASH & CARRYNO LIMITCASH & CARRY With Coupon. Expires 1/11/23 With Coupon. Expires 1/11/23 With Coupon. Expires 1/11/23 With Coupon. Expires 1/11/23 With Coupon. Expires 1/11/23 With Coupon. Expires 1/11/23 With Coupon. Expires 1/11/23 With Coupon. Expires 1/11/23 With Coupon. Expires 1/11/23 With Coupon. Expires 1/11/23 With Coupon. Expires 1/11/23 With Coupon. Expires 1/11/23 With Coupon. Expires 1/11/23 With Coupon. Expires 1/11/23 With Coupon. Expires 1/11/23 With Coupon. Expires 1/11/23 With Coupon. Expires 1/11/23 With Coupon. Expires 1/11/23 With Coupon. Expires 1/11/23 With Coupon. Expires 1/11/23 With Coupon. Expires 1/11/23 With Coupon. Expires 1/11/23 With Coupon. Expires 1/11/23 With Coupon. Expires 1/11/23 CASE AND VOLUME DISCOUNTS AVAILABLE. OUR STAFF HAS OVER 100 YEARS EXPERIENCE COMBINED. SCOTCH WHISKEY GIN & RUM PINOT GRIGIO VODKA TEQUILA INVER HOUSE 1.75L ................. $15.99 CLAN MACGREGOR 1.75L .......... $18.99 BALLANTINES 1.75L ................. $26.99 DEWARS WHITE LABEL 1.75L ..... $32.99 JOHNNIE WALKER BLACK 750ML $35.99 JOHNNIE WALKER BLACK 1.75L $71.99 PHILADELPHIA 1.75L ............... $15.99 EVAN WILLIAMS BLACK 1.75L ......... $26.99 CANADIAN CLUB 1.75L ................. $19.99 JAMESON IRISH WHISKEY 1.75L...... $51.99 JAMESON IRISH WHISKEY LITER $35.99 SEAGRAMS 7 1.75L $23.99 SAN NICOLA 1.5L ..........$6.99 SANTA MARINA 1.5L ......$8.99 CAVIT PINOT GRIGIO 1.5L $12.99 ECCO DOMANI 750ML .....$9.99 LUNA NUDA 750ML ...... $10.99 VODA 750ML ................$8.99 GILBEY'S GIN 1.75L $14.99 FLEISCHMANNS GIN 1.75L $15.99 TANQUERAY GIN 1.75L $39.99 BACARDI (PUERTO RICAN) RUM (GOLD OR SILVER) 1.75L $20.99 CAPTAIN MORGAN SPICED RUM 1.75L .................... $26.99 MALIBU COCONUT RUM 1.75L $32.99 VODA 5X 1.75L .................. $11.99 PLATINUM 7X 1.75L ............ $13.99 SVEDKA 1.75L ................... $19.99 NEW AMSTERDAM 80˚ 1.75L . $19.99 LVOV 80˚ 1.75L .................. $18.99 GREY GOOSE LITER ............ $29.99 JOSE CUERVO (GOLD OR SILVER) LITER .. $20.99 PATRON SILVER 750ML ................. $46.99 DON JULIO BLANCO 750ML ............ $48.99 HORNITOS PLATA 1.75L ................ $37.99 ESPOLON BLANCO 750ML .............. $26.99 MILAGRO SILVER TEQUILA 1.75L ..... $41.99 $799 $799 $599 $899 ALL TYPES ALL TYPES BRUT IMPERIAL FROM FRANCE ALL TYPES FROM LONG ISLAND WINTER WHITE FROM ITALY ALL TYPES LIMIT 2 CASES FROM CHILE ALL TYPES FROM ITALY ALL TYPES EXTRA DRY CHAMPAGNE ALL TYPES SPUMANTE GLEN ELLEN WINES GATO NEGRO WINES BOLLA WINES C.K. MONDAVI BALLATORE ANDRE 1.5 L 1.5 L 1.5 L $1699 $899 $1299 $1199 $799 $1199 $999 $1299 $2499 $899 ALMADEN WINES WOODBRIDGE SUTTER HOME WINES BARTENURA MOSCATO MOET & CHANDON PINDAR MARTINI & ROSSI 5 L BOX 750 ML 750 ML 1.5 L 1.5 L 750 ML 1.5 L 750 ML BLU 1.5 L 750 ML With Coupon. Expires 1/11/23 With Coupon. Expires 1/11/23 RED WINE SALE WHITE WINE SALE CORDIAL & CREAMS BLACKSTONE CABERNET 750ML .................. $6.99 MEIOMI PINOT NOIR 750ML ....................... $18.99 MARK WEST PINOT NOIR 750ML .................. $8.99 APOTHIC RED 750ML $9.99 BOGLE MERLOT 750ML .............................. $8.99 J. LOHR CABERNET 750ML ........................ $14.99 HESS CHARDONNAY (LAST TIME) 750ML ....... $8.99 MATUA SAUVIGNON BLANC 750ML ............ $10.99 BOGLE CHARDONNAY 750ML ..................... $8.99 CUPCAKE CHARDONNAY 750ML $8.99 KIM CRAWFORD SAUVIGNON BLANC 750ML $14.99 MOSELLAND RIESLING 750ML .................. $12.99 BAILEY'S IRISH CREAM 750ML ................. $29.99 MOLLY'S IRISH CREAM 750ML ................. $12.99 OLD NEW ENGLAND EGG NOG LITER ............ $9.99 EVAN WILLIAMS EGG NOG 750ML ................ $8.99 RUM CHATA 1.75L ................................ $41.99 FULTONS PUMPKIN CREAM 750ML .............. $8.99 SAMBUCCA ROMANA 750ML $25.99 OLE SMOKEY MOONSHINE CREAM 750ML $19.99 CHAMBORD 375ML $19.99 CHAMPAGNE ALL TYPES KORBEL $4199 750 ML Wines & Liquors 842-7633 WE HONOR ALL LOCAL COMPETITORS’ COUPONS Modica 1279 Sunrise Hwy., Copiague NEW YEAR’S SPECIALS MUST PRESENT AD FOR COUPON PRICE OPEN NEW YEAR’S EVE 9AM-9PM CLOSED NEW YEAR'S DAY In The Big Lots Shopping Center 407694N122822 HOURS: MON-THURS 9am-8pm, FRI & SAT 9am-10pm, SUN 12pm-8pm PROSECCO $1499 $1199 750 ML 1.5 L LA MARCA FROM ITALY SPARKLING BLUE MOSCATO PROSECCO FROM ITALY ASTI SPUMANTE FROM ITALY AMOR DE MAR $799 750 ML With





















































16 WEST BABYLON NORTHSOUTH BAY’S NEIGHBOR NEWSPAPERS WEDNESDAY DECEMBER 28, 2022 • WWW.LONGISLANDMEDIAGROUP.COM SALES • REPAIRS • INSTALLATIONS GARAGE DOORS & OPENERS DOOR OFF TRACK? BROKEN PREPARED!WE’RESPRINGS? Preventative Maintenance & 20-Point Safety Inspection $99 Tune-Up Special Prepare your garage system to operate at its best at all times. Call today to have a professional technician complete a proper maintenance for your system. New Sears Steel 1000 Series Supplied & Installed Includes hauling away old door, all new tracking and hardware. NO TAX! Other color & options available, mostly at no additional cost. $1,400 8x7 Single Car Garage Hardware Rebuild 16x7 Double Car Garage Hardware Rebuild Save Money & Overhaul Your Existing Door! Get Your Springs, Cables, Pulleys & Rollers All Completely Replaced! Coupon may not be combined with any other offer. Must be presented at time of service. Offer expires 3/30/23. $699 $899 Craftsman 1/2 HP Chain Opener Includes 2 Remotes, Outside Keypad, Wall Control & Sensor System. Wifi Enabled. Expires 3/30/23. $650 ULTRA RELIABLE Craftsman Ultra-Quiet Belt Drive $750 SUPER QUIET FREE IN HOME GARAGE DOOR ESTIMATES We warranty all of our products and services all under one roof! No referrals to manufacturers and hassle free! 516-433-3231 • 631-973-3001 WWW.SEARSGARAGEDOORS.COM EMERGENCYAVAILABLESERVICES 404376N122822 NEW YORK GARAGE SYSTEMS (SEARS® AFFILIATE) CONTEMPORARY FASHION “Looking Stylish Doesn’t Need To Break e Bank” from Petite to Plus Sizes 3839C MERRICK RD. • SEAFORD 516-221-2246 HOURS: SUN 10-3PM, MON-WED 9-5PM, THURS-SAT 9-6PM UNIQUELY YOURS • 221.2246 LIMIT ONE PER CUSTOMER With Coupon. Cannot Be Combined With Any Other Offer. Expires 1/4/23 With Every $25 Spent On Gift Cards $5 FREE Perfect Gift For Teachers UNIQUELY YOURS • 221.2246 Excludes Private Shopping Events. Limit One Per Customer With Coupon. Excludes Gift Certificates. Cannot Be Combined With Any Other Offer. New Purchases Only. Expires 1/4/23 Your Entire Purchase 25% off www.shopuniquely.com SHOP IN STORE OR ONLINE AT WWW.SHOPUNIQUELY.COM VOTED BEST OF LI WOMEN’S FASHION STORE 2022 407708N122822 407666BN122822
LEGAL NOTICE TO TAXPAYERS
Notice is hereby given taxpayers of the Town of Babylon, that the Undersigned Receiver of Taxes has received the 2022/2023 Tax and Assessment Roll and Warrant.
She will accept payment for taxes at her office in the Town Hall, 200 East Sunrise Highway, N. Lindenhurst, N.Y. 11757 or by mail, beginning December 2022 daily between the hours of 9:00 a.m. to 4:00 p.m. The Tax Office will be closed on Saturdays, Sundays and Holidays. First half taxes are due December 1, 2022 payable to January 10, 2023 without penalty.
After January 10, 2023 one percent per month will be added on the first half to May 31, 2023 after which date, additional interest will be charged by the County Comptroller at his office at County Center, Riverhead, N.Y. 11901.
The Town of Babylon Tax Office will be accepting partial payments with penalty. We offer e and credit card payment through a telephone service or by the internet which includes American Express, MasterCard, Visa or Discover. For payments by telephone call 1-800-2PAY 9829) or visit the web site at www.acipayonline.com. At the prompt, use Jurisdiction Code 4232. You must have your item number and tax amount available. Transaction fees will be charged to the taxpayer based on the amount of the total charge. Total amount Warrant to be collected by the Receiver of Taxes for the 2022/2023 tax year is $809,266,455.48.
Taxes become a lien December 1st of each year. First and Second half payments may be made at the same time.
JENNIFER MONTIGLIO RECEIVER OF TAXES
DATED AT BABYLON, N.Y.
December 12, 2022
2022/2023 TAX RATE ON $100 valuation - TOWN OF BABYLON Valuation of Hamlets and Incorporated Villages


Town Outside of Villages ............................ $187,045,547.00
Village of Amityville...................................... 14,294,553.00
Village of Babylon........................................ 19, 136,222.00
Village of Lindenhurst.................................. 29,217,380.00
A/C/LN/LS/WBN/WBS/B/NB/DP/F - 694 12/21, 12/28/22
2022-2023
TOWN OF BABYLON 2022-2023
Jennifer Montigio, Receiver of Taxes TAXABLE DISTRICTS
17 WEST BABYLON NORTHSOUTH BAY’S NEIGHBOR NEWSPAPERS WEDNESDAY DECEMBER 28, 2022 •
LEGALS LEGALS LEGALS LEGALS LEGALS LEGALS
Hundreds Of Food Items Donated During 2022 Holiday Drive-Thru Experience
Councilman and Human Services Chairman DuWayne Gregory extends a heartfelt thank you to all of the community members who donated non-perishable food items while visiting Town Hall during the 2022 Holiday Drive-Thru Experience.
Over the course of the three night event, the park’s department collected
hundreds of items that were transported directly to the food pantry. “The generosity of the people of Babylon is always strong, but especially during the holiday season,” said Councilman Gregory.

“On behalf of myself, my colleagues on the Town Board and our staff, thank you to everyone who helped keep our pantry stocked so
we can assist those in need throughout the holidays,” he added.
The Town of Babylon Food Pantry accepts donations year round and is located at 1 Commerce Boulevard in Amityville. Most needed items include: peanut butter, jelly, tuna, canned vegetables, soup, pasta, sauce rice and beans.
Recycling Is Good For The Economy HELPSY Stands Out in Job Creation!
Lindenhurst Moose Lodge 1421 883 South Broadway Lindenhurst, NY 11757
***
All of the Following events are for Members and Qualified Guests.
We Wish Happy and Healthy Holidays to All!
Our Lodge will be CLOSED January 1st.
Our Social Quarters Open ~ 6:00pm to 10:00pmSun, Mon, Tues, & Thurs. 6:00pm to 12:00amFriday & Saturday
** Kitchen Open Monday, Thursdays and Sunday 6:30 pm - 8:45 pm
Moose Corner
Social Quarters to Members who are in good standing. Please have your I.D. card
***
~Saturday December 31st~ Let’s Start The New Year Together!!
Social Quarters Annual NEW YEARS EVE PARTY!!! $10.00 pp. Includes Hot and Cold Buffet. & Champagne toast at Midnight. Come down and have some fun with your friends. Please Contact us for more details or to let us know you’ll be there, please don’t wait.
Bridgette F. 631-988-4589 Linda V. 631-957-2391
***
** Event Tickets are available in the Social Quarters. Please ask your server.
***
~Saturday Nights~ Queen of Hearts Drawing is at 9:00pm every Saturday.. Tickets are ONLY available in the
~~Our Lodge was asked to Join in the festivities for The New Years Eve Centennial Ball Drop!!!
Stop by the Hot Cocoa Booth at the Village Square and lend a hand 7:00pm to 9:00pm. Help bring it all back to the lodge and have some fun!!
***
~Monday January 2nd~
Lodge General Members Meeting 8:00pm. Board of Officers Planning Meeting 9:00 pm.
If you have a Question, Suggestion or Concerns. Please ask to speak with the Board Members on meeting nights, they are here to help you.
Contact The Lodge President Paul LaMartina 516-650-8903
***
~ Tuesday January 3rd~ WOTM Chapter 690 Social Meeting 7:00 pm
***
::SAVE THE DATES:: January 5th - Life-Line Screening 8:00am-5:00pm January 8thFamily Brunch January 14thCountry Western Night January 21stFamily Breakfast
All Members must present there Membership Card upon entering the building, If you do not have your Membership Card you must sign the guest book.
The statistics are in… recycling is not only good for the environment, but also for the economy. And a standout economic success story in recycling is HELPSY!
The environmental benefits of recycling are well documented and by themselves warrant a more sustainable lifestyle. With information gathered by the Recycling Economic Information Project (REI), an organization created in 2001 to encourage the development of an economic market for recycling and supported by the EPA, it is proven beyond a doubt that recycling not only conserves natural resources but recycling also strengthens our economy by creating jobs, wages and creating tax revenue.
A 2020 REI report showed the recycling industry (including glass, paper,
plastics, rubber, electronics, organic and construction and demolition materials) across the board created 681,000 jobs, $37.8 billion in wages, and $5.5 billion in tax revenue. Furthermore, on average… 1.17 jobs were created for every 1000 tons of recycled materials.
Rising above the rest by comparison, with 270 employees, HELPSY is the largest clothing collection company on the East Coast and collects 15,000 tons of textiles every year… amounting to 18 jobs for every 1000 tons.

“HELPSY’s environmental mission is to radically change the way people think about clothing reuse and recycling. In the process of serving this mission, it has created hundreds of living wage jobs, saved municipalities millions of dollars in disposal fees, and has reduced the enormous
environmental burden of the second most polluting industry in the world,” says Dan Green, Co-Founder and CEO of HELPSY.
Over the past year, HELPSY has worked with 113 municipal recycling departments and collected approximately 1.7 million pounds of textiles from those collaborations. Through a combination of clothing drives, home pick-ups, thrift store partners and clothing receptacles located in 10 states, HELPSY diverts nearly 30 million pounds of textiles from landfills every year. Considering those numbers, recycling clothes makes sense both environmentally and financially. For additional information about HELPSY or to join in our environmental preservation efforts, contact info@ helpsy.co.
The Babylon Chorale Auditions
The Babylon Chorale will hold auditions on Monday evening, January 9, 2023 starting with rehearsal at 7:30pm
at Sisters of St. Joseph Brentwood Campus. All voice parts are welcomed.
For further
information and current protocols, visit www.babylonchorale. org or email info@ babylonchorale.org
18 WEST BABYLON NORTHSOUTH BAY’S NEIGHBOR NEWSPAPERS WEDNESDAY DECEMBER 28, 2022 • WWW.LONGISLANDMEDIAGROUP.COM
HUNDREDS OF FOOD ITEMS DONATED - Councilman and Human Services Chairman DuWayne Gregory extends a heartfelt thank you to all of the community members who donated non-perishable food items while visiting Town Hall during the 2022 Holiday Drive-Thru Experience. Pictured: Councilman DuWayne Gregory with Parks Commissioner Daniel McKeon, Deputy Parks Commissioner Eva Rodriguez-Greguski, Human Services Commissioner Traci Fonville, and staff members from the parks department.
Continued On 19
Moose Corner









Continued From 18


Please Call the Social Quarters after 6:00pm, 631-226-4364 for more information on all Dates and Events Listed. Thank you for supporting our Community, Mooseheart, Moosehaven & Our Lodge. LIKE us on FacebookLOOM1421 (The Official Lodge Page) Check out our NEW website: http://www.mooselodge1421. com






























19 WEST BABYLON NORTHSOUTH BAY’S NEIGHBOR NEWSPAPERS WEDNESDAY DECEMBER 28, 2022 • WWW.LONGISLANDMEDIAGROUP.COM GARAGE DOORS G&M Garage Doors 631-277-3450 BROKEN SPRING REPAIR SPECIALIST SAME DAY SERVICES SUPERIOR QUALITY & COURTEOUS SERVICE VINYL, STEEL, WOOD, FIBERGLASS RESIDENTIAL & COMMERCIAL FREE ESTIMATES VISIT OUR SHOWROOM 254 ISLIP AVE., ISLIP 407636N122822 www.gandmgaragedoors.com OSHA Qualified Clopay Authorized Dealer Family Operated Since 1987 SIDING SIDING IS OUR SPECIALTY Siding • Trim Work • Windows Repairs • Gutters • Leaders • Capping INSULATE YOUR HOME AND SAVE ON YOUR ENERGY BILLS LOWEST PRICES OF THE SEASON! Deal Direct with Owner & SERVING YOUR AREA FOR OVER 20 YEARS V&P Siding & Window Corp. LICENSED/INSURED Lic. #27369-HI WE ACCEPT 631-321-4005 SAVE BIG $$$ NO JOB TOO BIG... NO JOB TOO SMALL!! CALL NOW FOR FRONT OR FULL HOUSE SPECIALS! 407612N122822 ROOFING STORM SPECIALISTS FREE ESTIMATES COMMERCIAL & RESIDENTIAL • ROOFS • SHINGLES • FLAT ROOFS • REPAIR SPECIALISTS LEADERS & GUTTERS • GAF CERTIFIED INSTALLERS 10% MILITARY DISCOUNT/ SENIOR DISCOUNT (MUST SHOW ID) AVAILABLE TO WORK IN ALL TYPES OF WEATHER Above All ROOFING Better Business Bureau Member CALL TODAY! Lic./Ins. #16739H.I. #HI8B43900000 WWW.ABOVEALLROOFINGLI.COM 631-665-3158 Ask About Our Extended Manufacturer’s Warranty. 380228N0122822 CHIMNEY SERVICE DONE BY FIREFIGHTERS THAT CARE SINCE 1982 STAINLESS STEEL LINERS CLEANING & REPAIR SPECIALISTS CHIMNEYS REPAIRED, REBUILT & TUCKPOINTING FULLY LICENSED & INSURED WWW.CHIMNEYKINGINC.COM CHIMNEY KING ENT, INC. NYC License # 2061397-DCA • Nassau County License # H0708010000 Suffolk County License # 41048-H 516-766-1666 • 631-225-2600 407596N122822 FREE ESTIMATES MASONRY SPECIALIST ELECTRICAL SERVICES 326155N122822 10% OFF PLUMBING REPAIRS PLUMBING STOPPAGES CORRECTED • Sewer Lines Electrically Cleaned • Sinks • Tubs • Washer Lines • Clogged Toilets • Septic Pumping Dec. 1A-787 • Chemicals • Cesspool Certification • Leaky Toilet Keeps Running • Loose Tank & Bowl • Leaky Sink Drain & Pipes • New Toilets Installed • Faucets Installed • Outside Faucet Leak • New Sinks & Gas Stoves Installed • Baseboard & Radiators • PEX Piping • Ejector Pumps • Dishwashers • Ice Makers • Gas Dryers & Pipes Installed Lic./Ins. CALL DAY/NIGHT CELL $25 OFF ANY REPAIR FREE ESTIMATES 516-924-4249 • 631-888-4006 MASTER PLUMBER LICENSED BABYLON, ISLIP, & INCORPORATED VILLAGE OF LINDENHURST CALL MIKE PLUMBING REPAIRS 363808N122822 CALL MIKE FUEL OIL GENESIS FUEL OIL 631-249-1438 www.genesisfueloil.com • HEAP ACCEPTED • SAME DAY DELIVERY • ON SITE FLEET FILLING AVAILABLE • DIESEL & OFF ROAD DIESEL • CREDIT CARDS SAME AS CASH • OPEN 7 DAYS A WEEK $4 OFF With Mention Of This Ad 369823N122822 OIL DELIVERIES / BURNER SERVICE 363884N122822 1/31/23 NEIGHBOR NEWSPAPERS SERVICE DIRECTORY $14995 + TAXCleaning Special includes Nozzle, Felt Filter and Strainer By Appointment Only C.O.D. Oil Service Contracts Starting at $200.00 AL’S OIL SERVICE INC. HIGH EFFICIENCY BIASI OIL BOILER SERVICE YOUR HIGH EFFICIENCY GAS BOILER BEFORE THE HEATING SEASON. WE SERVICE ALL MAKES & MODELS $6,195! With Riello Burner 32 Gallon Burderus Indirect Hot Water Heater Installed Call For Details NOW INSTALLING AND SERVICING NAVIEN GAS BOILERS 24 HOUR EMERGENCY BURNER SERVICE • TANK REMOVALS & INSTALLATIONS 631-842-9011 407435N122822 PUZZLE ANSWERS:
Fall Clean-ups, New Lawn In stallation Sod, Top Soil , Seed Mulch, Aeration Fall Flower Bed, Tree / Shrub Plan ting, Pruning & Trimming Complete Tree Service Any Style Fence Installation /Repair Driveways, Pati os, Pavers, Cobblestone Retaining Wa lls Power Washing (Cedar Houses, Siding, Decks, PVC Fences)










20 WEST BABYLON NORTHSOUTH BAY’S NEIGHBOR NEWSPAPERS WEDNESDAY DECEMBER 28, 2022 • WWW.LONGISLANDMEDIAGROUP.COM EMPLOYMENT SECTION NOTICE-Federal and State law make it unlawful for employers and employment agencies to advertise prospective employment where the job is limited as to age, race, creed, religion, color, national origin, sex, disability, genetic disposition or carrier status or marital status unless based upon a bona fide occupational qualification (BFOQ). This publication does not knowingly accept advertising in violation of these laws Help Wanted Help Wanted Help Wanted Drivers Wanted Full Ti me/Part Ti me with Clean CDL “A” or “B” Li cense. Overnight Shi ft. (7pm – 5AM) Unio n Sh op , Be ne fits Avai la bl e. F/T - 4 Days P/T 1-2 Da ys Call (631 ) 582-1144 Bus. Opportunities READY FOR A NEW YEAR & A NE W YOU? DO YOU HAVE A PHONE & WIFI? WORK FROM ANYWHERE! Make your own hours wi th a health & wellness company Get paid every Monday, travel opportuni ti es, bonus opportuni ti es & more! Ca ll LUCILLE for website link & company video! 631-38 3-1087 Advertise In This Section Call 631-226-2636 Advertise In This Section Call 631-226-2636 Autos Want ed Advertise In This Section Call 631-226-2636 Advertise In This Section Call 631-226-2636 Cable/Wiring CABLEMAN/ WIREMAN FLAT TVS MOUNTED WATC H TV FREE We Inst all HD Antennas Ge t local Ne twor ks & up to 80 HD Channe ls ! Phone Jack & Cable TV Extensions In stalled, Computer Networkin g CAT 5/6, Camera Systems, Stereo Surround Sound, Sound bars, Wires Hidden All Credit Cards Lic 54264-RE/Ins Visit Website www:davewireman 10% Veterans Discoun t-code “Sbay” Call Dave 516 433 WIRE(9 473) 631 667 WIRE(9473) TEXT 51 6 353 1118 Carpenter/Contract or ALL PHASES OF HOME REPAIRS, IMPROVEMENT & RENOVATION S OWNE R OPERATED FR OM MINOR RE PAIRS TO MAJOR RE NOVATI ON Basemen ts Bath, Kitchens Interior Doors, Floo ring, etc. Licensed/Insured Free Estimates Senior Discounts ACE CONTR ACTING CALL OR TEXT 631 432 3892 Electricians COMPLETE ELECTR ICAL SERVIC ES Residential Commercial •S ervice Upgrad es •Ind oo r/Ou tdoor Lighting •Res idential Wiring •P an el Replacement •Whole House Surge Protector •E V Charging Stations •Pool /Hot Tub Wiring •Hom e Stan db y Generators 24 Hr Emergency Se rvice Se ni or Disco unt s Call 631 .620. 0273 Heati ng & Ai r Condi ti oning Heati ng & Ai r Condi ti oning BOB THE BUILDER Handyman, Carpent er, Contra ctor 40 Ye ars Experience Specializing In Bathrooms, Kitchens, Fini shed Ba sement s, Extensions , Windo ws, Doors, Si ding, Decks, Power
Sheetrock, Spackle and Painting Family Owned & Operated. We Care. Lic#4168 5 Ins. 631-838-1223
LANDSCAPING & TREE
Landscaping & Tree Service licensed/insured Call Leno 631 365 5853 Regional GM Shopfitting Americas, Telecommuting position with extensive national and international travel. Mail resume to D. Gariti, D3 LLC, 75 Marcus Drive, Melville, NY 11747 407759N122822 Supply Management Specialist: Bellport, NY - to coordinate moving specialty lubricants for the aircraft & aerospace tooling industry to purchaser. Mail resume to R. Silverstein, The Ore-Lube Corp. 20 Sawgrass Drive, Bellport, NY 11713. 407761N122822 407674N122822 THE SIGN SHOP THE SIGN SHOP INC. 149 Pennsylvania Ave. Lindenhurst, NY 11757 EMAIL INQUIRES TO: MAIL@THESIGNSHOPINC.COM IS NOW HIRING General Shop Help FULL OR PART TIME Includes Assembly, Installation & Driver. Salary Comm With Exp. Starting At $15/hr GREAT OPPORTUNITY All Pets Animal Hospital in West Babylon is Now Hiring PART TIME POSITION EXPERIENCE IS PREFERRED Immediate Position Call Electra for Immediate Interview 631-376-1133 VET ASSISTANT & KENNEL HELP 400859N112322 $ 5000 Sign On Bonus ask for details NOW HIRING FULL TIME/PART TIME - CALL TODAY $ 20- $ 55 plus per hour 0% INTEREST 10% OFF 1-516-330-1346 403744N122822 COMPETITIVE PAY • PAID VACATIONS • PAID HOLIDAYS MEDICAL BENEFITS • ROTH IRA PENSIONS AA GET INSTANT CASH 631-445-1848 Junk/Running Cars Wanted. Get The Most Cash For Your Car! We Beat The Competition. Free Pick-Up Se Habla Espanol 371498N122822 JUNK CARS BOUGHT TOP CASH PAID! Licensed, Insured & Bonded. FREE 24 HOUR PICK-UP! SERVING LONG ISLAND FOR 35 YEARS CALL US LAST!! 631-532-0832 407738BN122822 HYUNDAI KIA EXPERTS! FOR SALE Mica White/Gray Wall Unit Dining Room Table 6 Chairs & Custom Table Pad All for $250 Like New Great Condition Call 516-680-9859 402527N122822 LOW LOW PRICES! PATMOS FUEL OIL 7 DAYS A WEEK Fuel Oil & 24 Hour Burner Service BOILER SERVICE & INSTALLATION 631.789.5867 631.387.5756 LATE NIGHT DELIVERIES NO PROMBLEM! OIL TANK INSTALLATIONS C.O.D. - H.E.A.P. OIL TRUCK DRIVERS NEEDED IMMEDIATE OPENINGS FULL OR PART TIME DOWNLOAD OUR APP PATMOSFUEL TO RECEIVE 3¢ OFF A GALLON OF OIL 396584N122822 BUYING? SELLING? RENTING? Place your ad in the Classifieds 631-226-2636 Ext. 276 THE power of CLASSIFIED! Call The Classifieds 631-226-2636 Pres s 2 Call The Classifieds 631-226-2636 Ext. 276 THE power of CLASSIFIED! THINKING ABOUT ADVERTISING YOUR BUSINESS and not sure how to get started? Call today and one of our experi enced Sa les Representatives will assist you. We c an help you with a lin e ad or a di splay ad. Let us at SOUTH BAY'S NEIGHBOR NEWS PAPE RS set up an adv ertising program for you. Y ou'll be glad you di d! Call 631-226-2636, Ext. 276 THINKING ABOUT ADVERTISING YOUR BUSINESS and not sure how to get started? Call today and one of our experienced Sa les Representatives will assist you. We c an help you with a lin e ad or a di splay ad. Let us at SOUTH BAY'S NEIGHBOR NEWS PAPE RS set up an adv ertising program for you. Y ou'll be glad you di d! Call 631-226-2636, ext. 276 BUYING? SEL LING? RENT ING? Place your ad in the Classi fieds 631 -2 26-2636 Ext. 27 6 Call Today and Ask About our Color Seasons Magazine (631) 226-2636 Press 276 LOOKING TO ADVERTI SE YOUR BUSINES S? Call Classified and one of our experienced sales representatives will help you. BIG BUDGET? SM ALL BUDGET? 631-226-2636, press 276 CLASSIFIED GETS RESULTS! Call today! 631-226-2636 631-226-2646
Washing
Landscaping COMPLETE
SERVIC ES
LG Guevara









21 WEST BABYLON NORTHSOUTH BAY’S NEIGHBOR NEWSPAPERS WEDNESDAY DECEMBER 28, 2022 • WWW.LONGISLANDMEDIAGROUP.COM Long Island’s Premier Hyperbaric Oxygen & Wound Care Conditions Treated: • Diabetic Ulcers • Osteomyelitis • Arterial & Venous Insuf ciency • Non Healing Fractures • Post Surgical Wound Complications • Compromised or Failing Skin Grafts 450 Sunrise Highway • Massapequa NY 11762 Of ce: 516-809-9217 • Fax: 516-487-4156 www.nshyperbarics.com Kevin Harrison MD FACS 407704N122822 NOW OPEN HAPPY NEW YEAR!











22 WEST BABYLON NORTHSOUTH BAY’S NEIGHBOR NEWSPAPERS WEDNESDAY DECEMBER 28, 2022 • WWW.LONGISLANDMEDIAGROUP.COM Full Rental Service • No Fee To Landlord If you’re currently listed with a broker, please disregard this offer. It is not our intention to interfere with that relationship. My Website has some good information Call When I Can Help • Free Price Analysis • Highest Selling Price • Free Home Warranty • Established 1977 Phone: 631-957-0500 Cell: 631-671-9172 Hank Cardello, BA, GRI Owner/Broker Certified NYS Instructor 407672BN122822 Questions On Licensing? New Island Realty Is Now Hiring Full & Part Time Agents Visit www.NewIslandRealty.com Where you can find recent home sales, available homes for sale, environmental information, school reports, sex offenders registry, mortgage calculations and much more. 308 35TH STREET • LINDENHURST • 631-226-9200 Mon-Thurs 11am-9pm • Fri & Sat 11am-9pm • Sun 12pm-9pm 407529N122122 FREE DELIVERY $15 MIN DELIVERY DRIVER WANTED Coupons Not Valid On Any Holidays! With Coupon. Exp. 1/11/23 $3799 +TAX & DEP. +TAX $2199 +TAX 6 GARLIC KNOTS LARGE 18” PIE $1699 With Coupon. Exp. 1/11/23 PICK-UP OR DELIVERY 6 GARLIC KNOTS SICILIAN or GRANDMA’S PIE FAMILY COMBO 1 18” PIE • BAKED ZITI CHICKEN PARMIGIANA HERO 6 MOZZARELLA STICKS 1-2 LITER SODA With Coupon. Exp. 1/11/23 $2799 3 HEROS SPECIAL +TAX With Coupon. Exp. 1/11/23 $2199 With Coupon. Exp. 1/11/23 With Coupon. Exp. 1/11/23 LET US DO THE COOKING *No Substitutes Allowed Full Tray Baked Ziti Or Penne Alla Vodka 1/2 Tray Chicken Parmigiana 1/2 Tray Eggplant Parmigiana 1/2 Tray Sausage & Peppers 1/2 Tray Meatballs 1/2 Tray Garlic Knots $23999* +TAX Father Time The Holiday Party 1/2 Tray Mozzarella Sticks or Fried Ravioli 1/2 Tray Pot Stickers or 1/2 Tray Sweet & Sticky Meatballs 1/2 Tray Fried Mushrooms or 1/2 Fried Zucchini 1/2 Popcorn Chicken or 1/2 Wings 3 Large Plain Pies 24 Wings 24 Garlic Knots PEPPERONI LOVERS 1 LARGE PIE COVERED IN PEPPERONI 12 PEPPERONI KNOTS +TAX 1LARGE PIE 1 DOZEN MOZZARELLA STICKS OR 1 DOZEN WINGS $2995 +TAX PICK-UP OR DELIVERY BBQ • HOT • HONEY BBQ TERIYAKI WITH BLEU CHEESE & CELERY FRESH NOT FROZEN 24 WINGS $3095+TAX With Coupon. Exp. 1/11/23 ALL PARMIGIANA • MEATBALL • CHICKEN • SAUSAGE • EGGPLANT With Coupon. Exp. 1/11/23 DOUBLE DEAL 1 18” PIE COVERED IN 2 TOPPINGS $2399 +TAX With Coupon. Exp. 1/11/23 $3499 1-18” PIE 1 SICILIAN PIE 12 GARLIC KNOTS 1-2 LITER SODA THE WHOLE GANG +TAX + DEP 2 LARGE 18” PIES 1 FREE TOPPING 1-2 LITER SODA 12 GARLIC KNOTS $3299 +TAX & DEP. With Coupon. Exp. 1/11/23 The Time Square 1/2 House Salad or 1/2 Caesar Salad 1/2 Sausage & Pepper or 1/2 Meatballs 1/2 Baked Ziti or 1/2 Penne Alla Vodka 1/2 Chicken Parm or 1/2 Chicken Francaise $159.99 +Tax $149.99 +Tax $89.99 +Tax VISIT US AT DOMINICKSPIZZAANDPASTA.COM Happy New Year! With Coupon. Expires 1/11/23 1 LARGE PIE 6 GARLIC KNOTS 2 LITER SODA $1999 +TAX 407671N122822
Support Group
Of
support
that will
to
and
Bereavement
Our Lady
Grace church at 666 Albin Ave., West Babylon, NY 11704 is forming a bereavement
group
meet on Saturdays from 9:30
11:00am
will run for 9 weeks, starting date is 2/11/23 and ends 4/08/23... call John 631874- 0210 or Fran 631587-1578
LOOKING TO ADVERTI SE YOUR BUSINES S? Call Classified and one of our experienced sales representatives will help you.
BIG BUDGET? SM ALL BUDGET? 631-226-2636, press 276
THINKING ABOUT ADVERTISING YOUR BUSINESS and not sure how to get started? Call today and one of our experi enced Sa les Representatives will assist you. We c an help you with a lin e ad or a di splay ad. Let us at SOUTH BAY'S NEIGHBOR NEWS PAPE RS set up an adv ertising program for you. Y ou'll be glad you di d! Call 631-226-2636, Ext. 276
Call The Classifieds 631-226-2636 Pres s 2
THINKING ABOUT ADVERTISING YOUR BUSINESS and not sure how to get started? Call today and one of our experienced Sa les Representatives will assist you. We c an help you with a lin e ad or a di splay ad. Let us at SOUTH BAY'S NEIGHBOR NEWS PAPE RS set up an adv ertising program for you. Y ou'll be glad you di d! Call 631-226-2636, ext. 276
Call The Classifieds 631-226-2636 Ext. 276
BUYING? SELLING? RENTING?

Place your ad in the Classifieds 631 -2 26-2636, Ext. 276
LOOKING TO ADVERTI SE YOUR BUSINES S? Call Classified and one of our experienced sales representatives will help you.
BIG BUDGET? SM ALL BUDGET? 631-226-2636, press 276

GET YOUR AD NOTICED! Call Our Classified Dept. 631-226-2636 press “2”
CLASSIFIED GETS RESULTS!
Call today! 631-226-2636 631-226-2646

HAVE AN APARTMENT TO RENT? Place your ad in our Classifieds 631 -2 26- 2636 Ex t. 276


BUYING? SEL LING? RENT ING? Place your ad in the Classi fieds 631 -2 26-2636 Ext. 27 6

Get Results Call Classifed 631-226-2636 Press “2”
TO place an ad in the CLASSIFIED section, call 631-226-2636, press “2” A sales representative will be happy to assist you
TO place an ad in the CLASSIFIED section, call 631-226-2636, press “2” A sales representative will be happy to assist you
TO place an ad in the CLASSIFIED section, call 631-226-2636, press “2” A sales representative will be happy to assist you
23 WEST BABYLON NORTHSOUTH BAY’S NEIGHBOR NEWSPAPERS WEDNESDAY DECEMBER 28, 2022 • WWW.LONGISLANDMEDIAGROUP.COM Thinking Of Selling? List Now While Inventory Is Still Low... We Have Proven Results Selling Above Asking Price. Contact Us Today For A Free No Obligation Home Evaluation And Selling Consultation! 265 Conklin Street • Farmingdale, NY • 516-752-8828 407752N122822 BETHPAGE $1,950 + Elec One Or Two Bedroom Apartment BETHPAGE $2,200 + Elec & Heat 2 Bedroom N. MASSAPEQUA $2,400 ALL 2 Bedroom, All Spacious Rooms, Ground Floor VALLEY STREAM $1,950 + Elec. 1 Bedroom, Spacious, Laundry RENTALS RENTALS RENTALS TOO NEW FOR PHOTO RENTALS Masonr y JAG MASONRY & LANDS CAPING Pavers, Patios, Drivew ays, Stoops, Cultured Stone Pool Areas, Etc! Free Estimates. Reasonabl e Prices & Reliable! Lic ensed & Insure d Lic. #59023-H References Avail abl e! Se Necesitan Albaniles Con O Algo De Experiencia. 516 -532- 234 7 Mi scel laneous Services Painting Paperhanging Painting Paperhanging Painting Paperhanging AFFORDABLE PROFESSIONAL PAINTING Interior / Exterior Deck Staining Power Washing Moldin gs/Trim Owner Operated 30 Yrs Experience Licensed/ Insured Discounts for Veterans/Seniors Free Estimates JMH PAINTING 516 495 3532 STEVE TSIMIS PAINTING & POWER WASHING CARPENTRY MOLDIN GS DRYWALL Exterior/Interio r Also - Specializing in Plaster Work and Skim Coating OWNER OPERATED 516 -433- 041 9 516 -270- 619 5 LIKE US ON FACEBOOK INSURED/LICENS ED # H0100280000 Plumbi ng AIR CONDITION ING PLUMBING & HEATING COMMERCIAL/ RESIDENTIAL Ac Repairs. Comp lete Installs Mini Splits, Oil to Gas Conversions, Heaters Furnaces, Bo ilers, Hot Water Heaters New Plumbing K O'Reilly Plumbing & Heating Licensed & Insured 631 626-6215 Tree Service CHEAP TREE REMOVAL Joe's Co mp lete Tree Service Inc. *Hazardous Tree Removal *Hazardous Dead Wood Removal *Storm Damage *Pro perty Line Trimming/LandClearing Hi ghest Qual ity Work Serving LI for 25 + yr s Joe wi ll Meet and Beat Writte n Es timate s Lic/Ins S-273 55 N-H2 90365- 000 0 WWW. Jo es Comp le te Tree Se rvice.co m Suf. 631 225 2075 Nas. 516 221 1205 Poems of the natural world to give flight to the mind and wings to the imagination. Available on Amazon. Call Audrey 631-893-3049 407601N122822 AYDIN PAINTING FREE ESTIMATES CALL MATT 631.871.3616 Licensed | Insured #39810-H References Available 407634N122822 WINTER SPECIALS • Painting • Sheet Rock • Spackling • Wallpaper Removal • Owner Operated • Interior • Exterior HAPPY HOLIDAYS Call Today and Ask About our Color Seasons Magazine (631) 226-2636 Press 276 BUYING? SELLING? RENTING? Place your ad in the Classifieds 631-226-2636 Ext. 276 THE power of CLASSIFIED!
APPETIZERS
Fried Calamari
1/2
$65 $100





Baked Clams Oreganata $65 $100
Mussels Marinara $60 $95
Stuffed Mushrooms $60 $85
Chicken Fingers $60 $80
Fried Zucchini $45 $75

Buffalo Or BBQ Wings $65 $115
Mini Rice Balls $60 $90
Jumbo Shrimp Cocktail $70 $105
Mozzarella Sticks $55 $80

Fried Ravioli $50 $75
PASTAS

1/2 Tray Full Tray
Nonna’s Pasta $65 $100

Baked Lasagna $60 $90
Baked Ziti $55 $85
Baked Stuffed Shells $60 $90

Baked Ravioli $60 $90
Penne Alla Vodka $55 $85


Fettucine Alfredo $55 $85
Spaghetti w/ Meat Sauce $50 $80
Pasta Primavera $55 $85

Penne Broccoli Rabe $70 $95


























Penne w/ Broccoli $50 $75
Penne w/ Broccoli & Grilled Chicken $70 $100
Pasta Bolognese $60 $95
Baked Manicotti $60 $90
Rigatoni Romano $60 $90
Pasta Pontanesca $55 $85
Rigatoni Catania $60 $95

Linguini & Clams $70 $105
Pasta Carbonaro $60 $85
Pasta With Spinach $50 $75
SALADS
1/2
Seafood Salad $75 $150
Tossed Garden Salad $35 $55 Caesar Salad $40 $60









Cold Antipasto Salad $50 $80
Mesclun Salad $45 $60
Nonna’s Salad $45 $60

ENTREES

Pollo

Ricky’s Chicken

1/2
$75 $110
Chicken Bruchetta $70 $105
Chicken Parmigiana $70 $105
Chicken Francaise $75 $110
Chicken Piccata $75 $110
Chicken Marsala $75 $110

Chicken Sorrentino $80 $120
Chicken Rollatini $80 $120

Nonna’s Chicken $75 $110
Chicken Verde $75 $110

Chicken Tuscano $80 $120
Chicken Scarpariello $80 $120
Vitello


1/2



Veal Parmigiana $95 $140
Veal Piccata $100 $150
Veal Marsala $100 $150
Veal Sorrentino $100 $150
Melanzana


Eggplant Parmigiana $55 $90
Eggplant Rollatini $65 $100 Stuffed Eggplant $65 $100
Pesce
1/2 Tray Full Tray
Shrimp Marinara $105 $140
Shrimp Scampi $105 $140
Shrimp Parmigiana $95 $140 Shrimp Francaise $105 $140 Shrimp Oreganata $105 $140


Nonna’s Shrimp $110 $160 Nonna’s Seafood Pescatore $120 $170











Favorites

24 WEST BABYLON NORTHSOUTH BAY’S NEIGHBOR NEWSPAPERS WEDNESDAY DECEMBER 28, 2022 • WWW.LONGISLANDMEDIAGROUP.COM #1 $2 OFF Any Pizza Pie $5 OFF Any Purchase (Of $35 Or More) 15% OFF Any Catering Order (Of $150 Or More) $300 $420 $145 Full Tray Chicken Parmigiana, Marsala or Francese Full Tray Penne Ala Vodka or Baked Ziti Full Tray Sausage & Peppers or Meatballs Full Tray Garlic Knots 1/2 Tray Salad Full Tray Chicken Parmigiana, Francese or Marsala Full Tray Penne Ala Vodka or Baked Ziti Full Tray Sausage or Meatballs Full Tray Eggplant Rollatini or Eggplant Parmigiana Full Tray Salad Full Tray Garlic Knots 1/2 Tray Chicken Parmigiana, Marsala or Francese 1/2 Tray Penne Ala Vodka or Baked Ziti 1/2 Tray Salad 1/2 Tray Garlic Knots Feeds 25-35 People Feeds 40-45 People Feeds 12-15 People +TAX +TAX +TAX #2 #3 Cannot Be Combined. Pre-Tax Amount. Expires 12/31/22 Cannot Be Combined. Pre-Tax Amount. Expires 12/31/22 Cannot Be Combined. Pre-Tax Amount. Expires 12/31/22 Cannot Be Combined. Pre-Tax Amount. Expires 12/31/22 Cannot Be Combined. Pre-Tax Amount. Expires 12/31/22 Cannot Be Combined. Pre-Tax Amount. Expires 12/31/22 CATERING PACKAGES CATERING
www.nonnabellas.com Cauliflower Crust & Gluten Free Pizza & Pasta Gift Certificates Available
MENU
Tray
Tray Full
Tray Full Tray
1/2 Tray Full Tray
1/2 Tray Full Tray
Sausage & Peppers $65 $100 Meatballs $65 $100
Tray Full Tray
Tray Full Tray
Gorgonzola Salad $45 $60 Greek Salad $40 $60
Christmas Wreath Choices: Chicken Parm, Eggplant Parm or Sausage & Peppers Stromboli only $35 WISHING EVERYONE A SAFE & HAPPY HOLIDAY SEASON! 765-5 Deer Park Ave., North Babylon • 631-669-1250 PARTY HEROS • Fried Eggplant ....................... $18/Ft • Grilled or Fried Chicken ......... $20/Ft • Italian or American ................. $18/Ft ALL PARTY HERO PRICES PER FOOT PLUS TAX • Chicken Parmigiana • Eggplant Parmigiana • Sausage & Peppers • Stromboli • Spinach or Broccoli • Calzones PARTY ROLLS $30 407747N122822
Caprese Salad $50 $70































































































































































































































































































































































































































































































































































































































































































































































































































































































